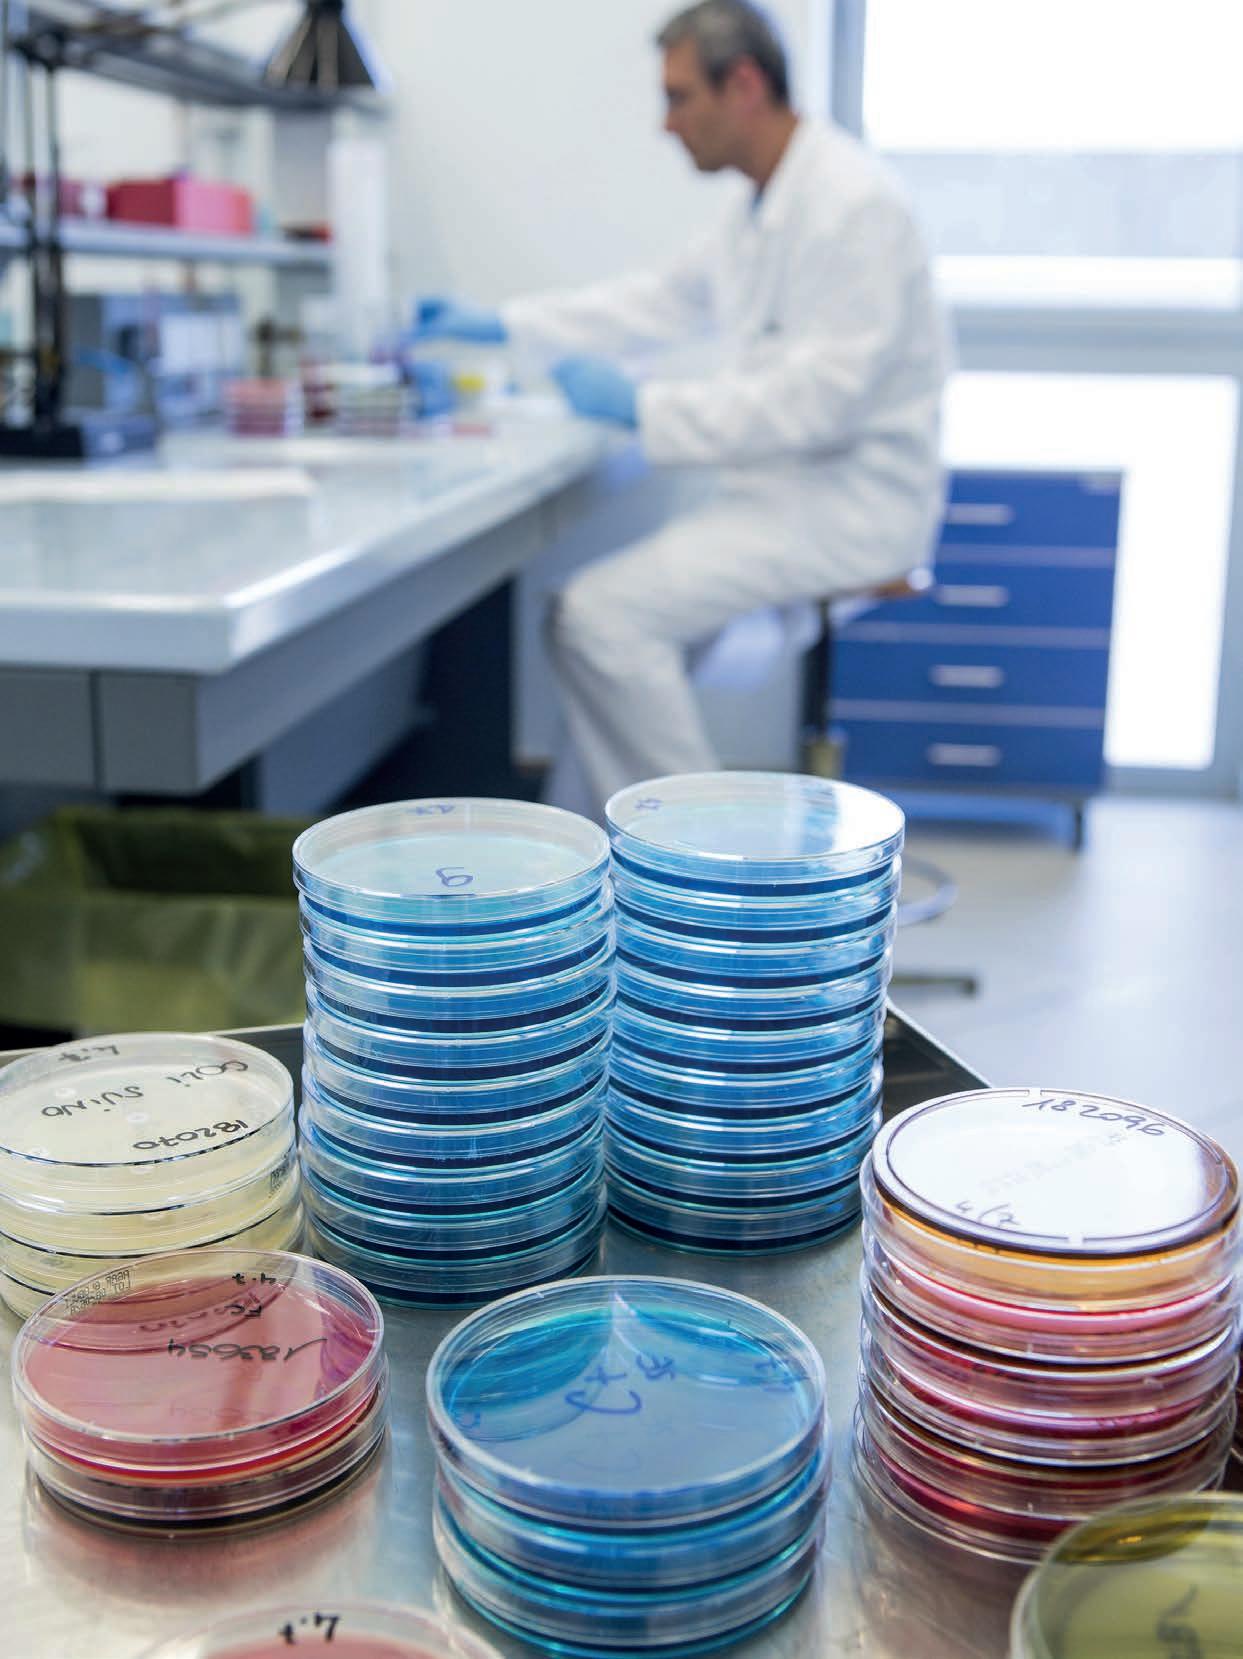

Una proiezione dello sviluppo della produzione mondiale di carne avicola fino al 2031


Gestione della lettiera
Confronto tra diete a base frumento e sorgo con due livelli di proteina grezza ed effetti sulle performance del pollo 5
2023
Zootecnica International –maggio 2023 –POSTE ITALIANE S.p.A. –Spedizione in Abbonamento Postale 70%, DCB Firenze


Nuove tramoggette della serie «Gió» Appositamente realizzate per grandi allevamenti, grazie alla facile regolazione della quantità di mangime e all'assenza della griglia (che impedisce ai pulcini di rimanere intrappolati), le tramoggette Gió presentano numerosi vantaggi: semplici da usare e veloci da pulire, portano ad una notevole riduzione dei costi di lavoro. CODAF Poultry Equipment Manufacturers • Via Cavour, 74/76 • 25010 Isorella (Brescia), ITALY Tel. +39 030 9958156 • Fax: +39 030 9952810 • info@codaf.net • www.codaf.net
EDITORIALE
Il cibo “cell-based” occupa sempre più interesse sui vari media. La cosiddetta “carne coltivata”, ottenuta prelevando cellula staminale, da animale vivo o da carne fresca, attraverso un complesso processo di trasformazione, diventa carne sintetica. Da una cellula si ottengono fino a diecimila chili di carne, in poche settimane.
Il primo hamburger realizzato in laboratorio all’Università di Maastricht costò 290mila euro. Secondo le previsioni degli esperti entro il 2030 la carne sintetica costerà quanto quella animale. Entro il 2040 potrebbe raggiungere il 20% del mercato globale delle carne, con un fatturato di 450 miliardi di dollari. Tra gli investitori che dimostrano di crederci, figurano Bill Gates, Richard Branson, Tyson Foods, Kellogg’s, Cargill; tra questi anche i Governi di Singapore e Israele. A Tel Aviv l’azienda SuperMeat offre già carne di pollo sintetica. In Italia, nel Centro di Biologia dell’Università di Trento, si stanno conducendo ricerche con risultati positivi. Negli Stati Uniti, a Singapore e in Israele il mercato è stato già autorizzato. Il Governo italiano vuole vietare il cibo sintetico: dalla carne al pesce, dal latte ai mangimi per l’alimentazione animale.
Si pongono nuovamente grossi quesiti etici e biologici. Ci sono correnti di pensiero che ripongono nel cibo sintetico una grande opportunità per la sua presunta sostenibilità. Per gli investitori si tratta di una grande occasione di lauti guadagni. Considerando il futuro del nostro Pianeta, occorrerebbe che la scienza desse le giuste informazioni, prima di tutto sul piano della sicurezza. Pensando poi a un incremento demografico insostenibile, al cambiamento climatico, alla deforestazione e alla minore disponibilità di acqua e di terreni agricoli, è ragionevole riflettere bene sulle soluzioni alternative.
Oggi ci è data ancora l’opportunità di scegliere e l’atteggiamento migliore resta sempre la moderazione e diete alimentari molto variate. Non occorre diventare vegetariani per salvare il mondo. La consapevolezza quotidiana, evitando sprechi, già aiuterebbe molto.
Sarebbe auspicabile non fare “tabula rasa”, mettendo in disparte la nostra storia, la nostra cultura per il cibo. Occorrerebbe dare più spazio a piccole realtà che si sono allineate sui principi di sostenibilità, rispettando la tradizione e la vera qualità.

La chiave del tuo profitto!
Il tempo passa, la qualità persiste!

75 anni di progresso
Da 75 anni, l’industria internazionale delle uova è in costante progresso e anche noi lo siamo!
H&N celebra la propria storia in un settore da sempre in continua evoluzione. Il ruolo importante che ci siamo ritagliati ci riempie di orgoglio: siamo all'avanguardia grazie alla nostra costante innovazione e crescita. Basti pensare alle nostre Super Nick e Brown Nick che rappresentano un concetto perfetto di uova: colore uniforme, guscio resistente e valore nutrizionale eccezionale. Grazie all’impegno e alla professionalità del nostro team, il cliente è sempre al centro dei nostri progetti. Siamo pronti a crescere ancora. Cresci insieme a noi! www.hn-int.com
H&N ITALIA SRL Via Ballarini, 1 – 27100 Pavia – Email: info@hnitalia.it – Tel.: +39 348 0154327



SOMMARIO ATTUALITÀ 4 LE AZIENDE INFORMANO 10 DOSSIER Accasamento e gestione della pulcinaia ...........................................................12 FOCUS Cinque fattori chiave per l’ottimizzazione della crescita dei polli da carne e dei risultati aziendali 16 MARKETING Una proiezione dello sviluppo della produzione mondiale di carne avicola fino al 2031 20 TECHNICAL COLUMN Gestione della lettiera 28 MANAGEMENT Stress da caldo: il livello di vitamina E e la fonte di zinco contano 34 NUTRIZIONISTICA Confronto tra diete a base frumento e sorgo con due livelli di proteina grezza ed effetti sulle performance del pollo 38 MARKET GUIDE.................................................................................. 44 GUIDA INTERNET .............................................................................. 48 38 28 20
Centocinquanta buyer internazionali presenti a Fieravicola
Alla manifestazione dedicata all’eccellenza avicola, che si tiene a Rimini dal 3 al 5 maggio, l’Algeria è il Paese ospite d’onore, al centro di un focus dedicato al Mediterraneo.
risultato confermato e raggiunto grazie all’impegno di ICE Algeri e del suo direttore Gabriele Barone.
A seguito della forte presenza di operatori internazionali che caratterizzerà questa edizione della manifestazione, gli espositori potranno usufruire del servizio di piattaforma b2b per fissare gli appuntamenti business preventivamente. La piattaforma è stata attivata già a inizio aprile, in modo da consentire di comporre una fitta agenda di contatti.
Centocinquanta buyer internazionali saranno presenti, per la prima volta, all’edizione di Fieravicola che si tiene dal 3 al 5 maggio a Rimini. Un risultato straordinario raggiunto grazie a un forte impegno nello sviluppo internazionale della manifestazione e la collaborazione di ICE,
l’Agenzia Italiana per la promozione all’estero. I buyer provengono dal nord Africa, Sahel, Turchia ed Est Europa.
“La presenza alla manifestazione di un numero così cospicuo di interlocutori esteri assicura la svolta internazionale che è stata uno degli obiettivi strategici di questi anni, nonostante le difficoltà del periodo legate alle crisi sanitarie e internazionali”, dichiara il presidente di Fieravicola, Renzo Piraccini. “Oggi possiamo dire che questa caratterizzazione internazionale ha buone fondamenta e che il bacino del Mediterraneo potrà divenire uno dei focus principali per le iniziative future dedicate alla filiera avicola”.
In questo contesto l’Algeria sarà presente come Paese ospite d’onore a Fieravicola con una delegazione, un
La manifestazione, organizzata da Fieravicola srl in collaborazione con Assoavi e UnaItalia, si propone come vetrina specializzata in cui presentare l’intero processo produttivo del comparto avicolo, a iniziare dalle carni bianche e dalle uova e comprendendo tutte le sue segmentazioni: dalla mangimistica e la genetica, alle tecnologie e impianti di lavorazione e confezionamento, trasporto e logistica, attrezzature agricole per zootecnia, tecnologie per la sostenibilità ambientale, marketing.
Fieravicola sarà occasione di contatti business e di momenti di approfondimento grazie a un’importante convegnistica sui principali focus di interesse della filiera.
Fieravicola si svolgerà dal 3 al 5 maggio in contemporanea a Macfrut al Rimini Expo Centre: la sinergia tra le due fiere ha infatti dimostrato di creare un appuntamento che funge da grande hub per l’agrifood e ne potenzia l’appeal internazionale.


4 - attualitàATTUALITÀ
Relazione EFSA, ECDC, EURL sull’Influenza Aviaria: basso il rischio per la popolazione Ue
Continua a evolversi in Europa e a livello mondiale la situazione dell’Influenza Aviaria: sono stati di recente segnalati nuovi focolai nei volatili e infezioni occasionali nei mammiferi.

state rilevate mutazioni associate ad adattamento genetico ai mammiferi, sia in mammiferi che in volatili.
Attenzione massima in tutti gli allevamenti animali
Nei Paesi extra-Ue sono stati recentemente segnalati alcuni casi di sporadiche infezioni di Influenza Aviaria nell’uomo, ma il rischio per la popolazione europea rimane basso. Questa è la conclusione finale dai risultati evidenziati nell’ultima relazione congiunta realizzata dall’Autorità europea per la sicurezza alimentare (EFSA), dal Centro europeo per la prevenzione e il controllo delle malattie (ECDC) e dal Laboratorio di riferimento dell’Ue (EURL). Anche se sono state segnalate sporadiche infezioni nell'uomo, che hanno causato grave malattia o esiti fatali, questi casi restano tuttavia un evento più che raro e casuale.
Scarsa trasmissibilità agli esseri umani
La maggior parte delle infezioni gravi rilevate di recente nell’uomo nei Paesi extraeuropei sono direttamente connesse a persone esposte ad animali infetti o deceduti, a personale addetto che non aveva rispettato le misure di sicurezza e non aveva indossato dispositivi di protezione individuale, in particolare in piccoli allevamenti privati.
L’ECDC stima che il rischio per la popolazione europea sia basso, e da basso a moderato per i lavoratori addetti negli allevamenti e altre persone a contatto con volatili e mammiferi morti o malati e potenzialmente infetti. L’ECDC conferma inoltre che i virus HPAI attualmente in circolazione sono sensibili ai farmaci antivirali attualmente disponibili per l’uomo, e che questi virus si legano di preferenza ai recettori di tipo avicolo, presenti nei volatili, e non ai recettori umani. In alcuni dei virus circolanti sono
Recenti episodi di mortalità di mammiferi, come quelli avvenuti fra i leoni marini, suggeriscono una potenziale trasmissione del virus HPAI anche tra i mammiferi. In questo contesto gli scienziati dell’EFSA e dell’EURL raccomandano di estendere e potenziare la sorveglianza ai mammiferi selvatici e d’allevamento, in particolare ai visoni americani e ai suini in quelle zone dove l’HPAI è particolarmente attiva e circolante.
Fonte: EFSA
Biolab 2000 esegue analisi chimiche dei mangimi, nuclei, cereali e foraggi per l’alimentazione animale che prevedono:

• Analisi del cartellino
• Coccidiostatici
• Micro/macroelementi
• Valori nutrizionali
• Analisi multiresiduali
I NOSTRI SETTORI:
• Vitamine
• Micotossine
• Analisi microbiologiche

• Pesticidi
Diagnostica Veterinaria • Agroalimentare • Zootecnico, Analisi chimiche • Biologia molecolare
• PCR-OGM • Analisi delle acque potabili e di scarico
- maggio 2023 - 5 ATTUALITÀ
www.biolab2000.it
BIOLAB 2000 S.r.l. • Via E. Fermi,
17 • 37060 Lugagnano di Sona (VR) Tel: 045 86 80 943 • FAX: 045 86 99 707 • Email: biolabvr@tiscalinet.it
Colza e soia geneticamente modificate permesse da Bruxelles negli alimenti e nei mangimi
La Commissione europea ha autorizzato due colture geneticamente modificate per uso alimentare e mangimistico: si tratta della colza, autorizzata per la prima volta, e della soia, che riceve invece un rinnovo.
Le autorizzazioni sono state quindi adottate autonomamente da Bruxelles e sono valide per 10 anni. Tutti i prodotti ottenuti da questi Ogm saranno comunque soggetti alle norme dell’Unione europea in materia di etichettatura e tracciabilità.
Dopo una fase iniziale caratterizzata da particolare cautela, sotto la spinta di movimenti ambientalisti e associazioni di piccoli produttori, l’Unione europea in questi anni sta mutando il suo approccio nei confronti degli Ogm. La Commissione europea dichiara di seguire i continui progressi della moderna biotecnologia “per valutare come l’Ue possa trarre vantaggio dall’innovazione nel settore agroalimentare” senza però compromettere elevati standard di sicurezza.
Nell’ultimo decennio sono state sviluppate nuove tecniche, come quelle di cosiddetto “editing del genoma”, che prevedono di manipolare il Dna di una pianta migliorandone determinate caratteristiche senza dover inserire Dna esterno.
Queste colture, geneticamente modificate, sono state sottoposte a una procedura definita “completa e rigorosa” che, secondo gli esperti, garantirebbe un elevato livello di protezione della salute umana, animale e dell’ambiente.
L’autorizzazione si basa su un parere dell’Autorità europea per la sicurezza alimentare (EFSA), che aveva emesso una valutazione scientifica favorevole, concludendo che questi organismi geneticamente modificati (Ogm) sono sicuri quanto le loro controparti convenzionali. Da sottolineare che, rispetto a questa scelta, gli Stati membri non hanno raggiunto una maggioranza qualificata a favore o contro l’autorizzazione in seno al Comitato permanente e al successivo Comitato d’appello.
Nel novembre 2019 il Consiglio degli Stati membri ha chiesto alla Commissione europea di fornire uno studio sulle nuove tecniche genomiche, pubblicato nel 2021. Sulla base dei risultati emersi, l’esecutivo europeo ha avviato un’azione politica sulle piante prodotte da mutagenesi e cisgenesi mirate, che comporterà una valutazione d’impatto, che a sua volta includerà una consultazione pubblica.
L’iniziativa ha come obiettivo di creare un nuovo impianto normativo per i prodotti vegetali geneticamente modificati senza che debbano ricadere negli stretti vincoli stabiliti nella direttiva vigente del 2001. Le tecniche genomiche, secondo i funzionari europei, contribuiranno ad assicurare il raggiungimento degli obiettivi del Green Deal europeo e della Strategia dal campo alla tavola Farm to Fork
Fonti: www.sivempveneto.it; www.agrifoodtoday.it

6 - attualitàATTUALITÀ
Passaggio automatico dalla fase pulcino alla fase adulta con il sistema a “finestrella”.


Piatto basso utilizzabile dal primo all’ultimo giorno. Nessun pulcino intrappolato nel piatto.
Piatto studiato per evitare lo spreco del mangime.


COMPLETAMENTE AUTOMATICA



- maggio 2023ATTUALITÀ AZA International s.r.l. Via Roma 29 24030 Medolago (BG) Italy Phone (+39) 035 - 901240 - E-mail: info@azainternational.it QUALITY MADE IN ITALY Visualizza tutte le informazioni su Pratika www.azainternational.it PRATIKA
più innovativa tramoggetta per polli da carne
La
VOGLIO AZA! CLACK UN SECONDO PER CHIUDERE CLICK
SECONDO PER APRIRE SUPPORTO ROBUSTO FACILE PULIZIA
UN
Controlli ufficiali legati alla tutela del benessere delle galline ovaiole nell'Unione europea
La Commissione europea ha pubblicato la relazione sui controlli ufficiali legati alla tutela del benessere delle galline ovaiole in ogni fase della produzione.
e pollastraggio riduce il numero di controlli sul benessere negli incubatoi e negli allevamenti di pollastre.
Buone pratiche rilevate in Italia
Periodicamente, le autorità italiane danno corso a uno specifico progetto di verifica volto a conoscere la situazione del settore e a ispezionare le aziende estraendole su base casuale dal database degli stabilimenti. Accanto alla sistematicità del metodo di controllo, la DgSante rileva per l’Italia lo sviluppo di buone pratiche di verifica della densità di allevamento e, in particolare, che sia rispettato il divieto di muta forzata.
Le misure per il benessere delle galline ovaiole sono variabili all’interno dell’Ue nonostante una legislazione comune che viene sostanzialmente fatta rispettare dagli Stati membri attraverso i propri controlli ufficiali. Le differenze si ripercuotono sullo stato di benessere degli animali e sul posizionamento dei produttori nel mercato europeo. In sintesi, questi sono i risultati delle conclusioni della relazione pubblicata di recente dalla Direzione Generale Salute (DgSante) della Commissione europea.

Panoramica europea
La relazione riferisce i risultati di un progetto europeo che nel 2021 ha sottoposto a verifiche nove Stati membri (fra i quali l’Italia) e somministrato questionari ad altri sedici. Ne è scaturita una panoramica europea dei controlli ufficiali sul benessere delle ovaiole dove spiccano le migliori pratiche riscontrate e nel contempo le maggiori criticità comuni.
La DgSante ha osservato che i Paesi che hanno introdotto misure aggiuntive ai già rigorosi parametri di controllo previsti dall’Unione europea hanno conseguito livelli di benessere maggiori, ma anche creato le condizioni ideali per potenziali disparità tra i produttori sul mercato europeo. Inoltre, l’assenza di specifici requisiti di benessere per le galline giovani, specificamente nella fase pulcinaia
Il database degli stabilimenti rappresenta un supporto per le attività delle autorità competenti, nonostante le informazioni inserite possano presentare delle imprecisioni, un rischio noto e gestito attraverso un regolare monitoraggio dei dati registrati e raccolti.
Analisi dei dati raccolti per un migliore controllo
La relazione si sofferma sui dati registrati, in grado di coprire una vasta gamma di informazioni sulle condizioni di benessere delle galline ovaiole negli allevamenti, a livello nazionale, regionale e locale. Questa mole di dati migliora gli indirizzi da dare ai controlli e le informazioni per gli addetti. Questo sistema fornisce anche ai veterinari ufficiali una solida metodologia da seguire per rendere più efficaci i controlli sul benessere delle galline ovaiole negli allevamenti. Il rapporto mette in luce altre buone pratiche, menzionando l’Italia tra i pochi Stati membri che utilizzano indicatori di benessere animale.
I risultati della relazione della DgSante confluiranno nel lavoro in corso della Commissione per rivedere la legislazione sul benessere degli animali.
Fonti: www.sivempveneto.it; ec.europa.eu/newsroom/sante/items/782117/en
8 - attualitàATTUALITÀ
Capannone Avicolo Mobile

Capannone avicolo mobile di 60 m2 Professionale, produzione italiana, ideale per l’allevamento all’aria aperta. 5 capannoni




- maggio 2023 - 9 ATTUALITÀ
Agritech
Via Rimembranze,
25012
Tel.
Fax
www.agritech.it
in un camion completo
s.r.l.
7
Calvisano (BS) Italy
+ 39 030 9968222 r.a.
+ 39 030 9968444 commerce@agritech.it
MET-OIL rivoluziona la sanitizzazione negli allevamenti

Presentata a FierAvicola - Macfrut una nuova soluzione di MET Medical Equipments
Technologies che sfrutta il potere igienizzante dell’ozono offrendo un vantaggio esclusivo agli operatori del settore zootecnico: può essere utilizzata senza svuotare gli allevamenti.

Un connubio di ozono e olio di girasole biologico per la sanitizzazione degli allevamenti a beneficio di tempo e salute degli animali. La svolta, presentata a FierAvicola - Macfrut, arriva da MET Medical Equipments Technologies, azienda specializzata nella progettazione di impianti e generatori a ozono.

I risultati hanno scientificamente dimostrato l’efficacia di MET-OIL . Tale soluzione, dove l’olio fa da vettore all’ozono, non solo consente il controllo di inquinanti, reflui maleodoranti, sviluppando un’azione ossidativa, in particolare sul contenuto ammoniacale e rendendo l’ambiente inadatto per la colonizzazione da parte di insetti o altri infestanti, ma ha un impatto zero, tanto che nel caso in cui gli animali ne venissero a contatto non creerebbe loro alcun danno, essendo il prodotto realizzato con componenti biologici al limite del commestibile.

SEMPRE AGGIORNATI SULLE ULTIME NOVITA’ del

10 - le aziende informanoLE AZIENDE INFORMANO
settore avicolo con
Zootecnica International offre un’ampia panoramica sull’avicoltura con notizie, approfondimenti, interviste, tendenze di mercato e articoli tecnici e scientifici. Edita in tre lingue, italiano, russo e inglese, è diretta a tutti gli operatori della filiera avicola: allevatori, produttori di uova, case di selezione, incubatoi, mangimifici, aziende di lavorazione e trasformazione di carne avicola e di uova. zootecnica.it
SOLDI ALLA MANO







LEADER NELLA CONVERSIONE DI MANGIME

- maggio 2023 - 11
An Aviagen Brand << Scansiona qui per saperne di più o visita il nostro sito www.fcrleader.com
ACCASAMENTO E GESTIONE DELLA PULCINAIA
basi fondamentali per una deposizione di successo
La gestione dell’accasamento e della pulcinaia rappresenta una delle fasi più critiche dell’intera vita di una gallina ovaiola. Questa fase, combinata ad una corretta fase di svezzamento, fondamentale per ottenere pollastre di elevata qualità, è la base per ottenere un ciclo produttivo di successo.
Tuttavia nella pratica l’importanza e l’attenzione ai dettagli di questi periodi sono spesso trascurati. Qualsiasi mancanza o errore in questo periodo possono influenzare tutta la vita della gallina ovaiola e sono irreversibili.

TOOL BOX
Maneggiare con cura
I pulcini di un giorno sono creature molto vivaci e forti appena nati. La schiusa da un guscio resistente, le fasi di incubazione e di trasporto fino all’allevamento sono degli eventi stressanti che il pulcino deve affrontare.

D’altra parte, bisogna tenere presente che i pulcini sono anche sensibili e vulnerabili, totalmente dipendenti dalle condizioni ambientali, che siamo noi a regolare.
Di conseguenza devono essere maneggiati con cura e attenzione, facendo in modo che tutte le loro esigenze siano soddisfatte al meglio.
Trasporto
Per trasportare i pulcini dall’incubatoio all’azienda avicola devono essere utilizzati veicoli dotati di controllo ambientale.
Durante il tempo necessario al trasporto devono essere assicurate la giusta temperatura, umidità e ventilazione.
Preparazione del capannone
Tutte le misure devono essere adottate in anticipo, in modo da assicurare condizioni di accasamento adeguate e l’allestimento della pulcinaia.
L’obiettivo dovrebbe essere quello di scaricare e posizionare i pulcini il più rapidamente possibile. Prima del loro arrivo devono essere garantiti i massimi livelli di biosicurezza.

Calore e umidità
I pulcini non sono in grado di regolare la propria temperatura corporea durante i primi giorni di vita. Pertanto una temperatura ambientale errata ha un impatto negativo diretto sulla loro temperatura corporea.
Al momento dell’accasamento e durante la fase di pulcinaia può essere garantita la temperatura corporea ottimale solo attraverso le giuste condizioni ambientali, incluse una corretta temperatura dell’ambiente e l’umidità relativa, oltre alla ventilazione minima per fornire aria fresca e la giusta quantità di ossigeno.
Se sottoposti a basse temperature corporee, i pulcini non sono in grado di regolare il loro metabolismo. Le conseguenze negative sono devastanti, come il rischio di infezione del sacco vitellino, abbassamento delle difese immunitarie, maggiore sensibilità a infezioni batteriche, ridotto sviluppo corporeo e alti livelli di mortalità
I migliori indicatori per valutare la corretta temperatura e le condizioni ambientali sono il comportamento del pulcino e la sua temperatura corporea, misurata con un termometro da neonato.

ITA
ACCASAMENTO E GESTIONE DELLA PULCINAIA 2023
MANAGEMENT
Acqua e mangime
Un immediato e facile accesso all’acqua fresca e pulita e a un mangime di buona qualità è essenziale per lo sviluppo del tratto gastrointestinale e del sistema immunitario e aiuta il sacco vitellino ad essere riassorbito più rapidamente.
Il corretto tipo di alimentazione e la sua struttura, la giusta temperatura dell’acqua e la regolazione dell’altezza degli abbeveratoi sono essenziali. Controllare i gozzi alcune ore dopo l’accasamento e durante i primi giorni è il modo migliore per valutare l’assunzione di mangime da parte dei pulcini.


Al momento dell’accasamento e nei giorni successivi deve essere garantita un’alta intensità luminosa proveniente da luci adeguate, senza punti d’ombra. Bisogna assicurarsi che i pulcini di un giorno trovino acqua e cibo e si adattino nel nuovo ambiente.
Il programma di luce intermittente rappresenta uno strumento semplice per stimolare i pulcini più deboli rispetto a quelli più forti e per garantire loro un periodo di riposo e un periodo di attività.
Questo strumento può essere applicato dalla prima settimana fino ai 10 giorni di vita, determinando un comportamento più uniforme e un maggiore aumento del peso corporeo del gruppo, riducendo la mortalità nelle prima settimana.
Comportamento dei pulcini
Il comportamento dei pulcini è un ottimo indicatore del loro benessere e delle corrette condizioni di accasamento, in particolare di quelle relative alla temperatura.
L’indicatore migliore per valutare la corretta temperatura del capannone, oltre al comportamento del pulcino, è la misurazione della loro temperatura corporea: quella ottimale è di 40-41 °C.
Temperature troppo alte: i pulcini si allontanano dalla fonte di calore, abbassano le ali e iniziano ad ansimare e sono meno rumorosi.
Temperature troppo basse: i pulcini si affollano e si ammassano vicino alla fonte di calore. Il loro pigolìo esprime disagio e si può osservare una minore mobilità.
Correnti d’aria o distribuzione irregolare della luce: se i pulcini si distribuiscono in zone particolari, alcuni dei motivi possono essere una temperatura non uniforme oppure zone scarsamente illuminate, o elevata ventilazione che crea correnti d’aria.
Temperatura corretta: i pulcini si muovono, bevono, mangiano e si dispongono nell’ambiente in maniera uniforme. I normali suoni che emettono non rappresentano un disagio.

Darkness Light 4h 4h 4h 4h 2h 2h 2h 2h TOOL BOX
Luce
La corretta altezza degli abbeveratoi e la giusta temperatura dell’acqua sono molto spesso trascurate nel periodo dell’accasamento e della prima fase di svezzamento. Il corretto angolo per l’abbeveraggio dei pulcini è tra 35° e 45° e una giusta temperatura dell’acqua è tra 20 e 25 °C.
Controlli regolari dei gozzi alcune ore dopo l’accasamento sono di aiuto per valutare l’assunzione del mangime e rappresentano uno dei migliori indicatori per garantire le corrette condizioni ambientali.
Conclusione
Occorre prestare particolare attenzione ai pulcini appena nati durante i loro primi giorni di vita. L’accasamento deve avvenire il più velocemente possibile, prestando la massima attenzione a tutto il periodo di accasamento.
In particolare la corretta temperatura ambientale e l’umidità relativa sono uno dei parametri più importanti, specialmente nei primi 5 giorni, dato che i pulcini non sono ancora in grado di regolare da soli la propria temperatura corporea.
Indubbiamente il corretto accasamento e primo svezzamento, oltre a una gestione ottimale dell’allevamento per ottenere pollastre di ottima qualità, rappresentano le basi fondamentali per un buon inizio del periodo di produzione e la chiave per un ciclo di deposizione di successo.
Disclaimer
Questo articolo, tratto da Tool Box Lohmann, rimane di proprietà di LOHMANN BREEDERS. Non è possibile copiarne o distribuirne alcuna parte senza previo consenso scritto di LOHMANN BREEDERS. Tradotto da Gianluca Selva, ALI LOHMANN, Distributore LOHMANN BREEDERS in Italia

Per ulteriori informazioni e altri articoli visitare il sito: www.lohmann-breeders.com
o contattare direttamente:
LOHMANN BREEDERS GMBH
Am Seedeich 9 – 11 - 27472 Cuxhaven / Germania
E-mail: info@lohmann-breeders.com
45º 35º ITA ACCASAMENTO E GESTIONE DELLA PULCINAIA 2023
Cinque fattori chiave per l’ottimizzazione della crescita dei polli da carne e dei risultati aziendali
Esistono azioni specifiche che possono essere intraprese per aiutare la crescita dei polli da carne secondo un ritmo più sano e ottimale: mediante il miglioramento di diversi fattori all’interno dell’ambiente, infatti, è possibile ottenere notevoli miglioramenti in tutto il gruppo, con un impatto positivo sui risultati aziendali.

16 FOCUS - focus -
In questo articolo illustreremo cinque modi per aiutare i polli da carne a migliorare il rendimento e a raggiungere il pieno potenziale. Assumendo il controllo dei seguenti fattori è possibile influenzare e stimolare in modo positivo la crescita e il benessere ottimali dei volatili.
1. Alimentazione equilibrata
Uno degli aspetti più importanti del settore zootecnico dell’avicoltura consiste nell’alimentare i volatili con i mangimi corretti. Un’alimentazione equilibrata aiuta a garantire che i polli da carne crescano secondo un ritmo sano e possano raggiungere il pieno potenziale. A tal fine, è possibile alimentarli con un mangime ad alto contenuto proteico durante la fase di crescita e garantire sempre l’accesso all’acqua dolce per mantenere gli animali ben idratati, poiché l’acqua è fondamentale per favorire la digestione del cibo.
ECO Unit

2. Allevamento sicuro
Non bisogna sottovalutare le scelte corrette in materia di genetica quando si tenta di ottimizzare il rendimento e la crescita dell’avicoltura. Ad esempio, alcune razze presentano una crescita più rapida in modo naturale rispetto ad altre. Ogni razza richiede una gestione specifica per contribuire alla crescita secondo il proprio ritmo ottimale. È importante scegliere la razza giusta in base agli obiettivi aziendali, in modo da poter gestire i diversi parametri di conseguenza.
3. Condizioni del pollaio
Il pollaio dei polli da carne implica la necessità di disporre di uno spazio sufficiente per consentire agli animali di spostarsi e fare esercizio all’interno della stalla. Si tratta di un aspetto fondamentale affinché i polli da carne sviluppino muscoli e ossa robusti. Inoltre, è essenziale cre -
Clima sano, risparmio di gas
La qualità dell’aria in uisce sulle prestazioni degli uccelli
L’ ECO Unit crea un usso d’aria salubre con riscaldamento e ra reddamento aggiuntivi che consentono di mantenere una temperatura uniforme in casa per tutto l’anno.
• Risparmio no al 75% sulla bolletta del gas
• Riduzione del 35% dei livelli di ammoniaca
• Migliore FCR
• Migliore lettiera
• Circolano no a 30.000 m3 d’aria all’ora
Per maggiori informazioni visitate il sito
www.vencomaticgroup.com.




Giacomo Pallavicini, Area Sales Manager Italy
Tel. +39 3478626334
giacomo.pallavicini@vencomaticgroup.com
- maggio 2023 - 17 FOCUS
Ordinate ora e appro ttate di questo inverno!
“Uno degli aspetti più importanti del settore zootecnico dell’avicoltura consiste nell’alimentare i volatili con i mangimi corretti. Un’alimentazione equilibrata aiuta a garantire che i polli da carne crescano secondo un ritmo sano e possano raggiungere il pieno potenziale. A tal fine, è possibile alimentarli con un mangime ad alto contenuto proteico durante la fase di crescita e garantire sempre l’accesso all’acqua dolce per mantenere gli animali ben idratati, poiché l’acqua è fondamentale per favorire la digestione del ciboˮ
are un ambiente che consenta loro di mantenere il ritmo di crescita senza disturbi o lesioni fisiche.
4. Temperatura
È possibile ottenere l’ambiente migliore e la crescita ottimale quando la temperatura nel pollaio è compresa tra
21-24 °C. Infatti, qualsiasi temperatura non compresa in tale intervallo limiterà la crescita. Tale condizione si traduce nell’assicurarsi che il pollaio sia adeguatamente isolato e che le temperature vengano controllate con grande precisione, poiché anche un lieve scostamento dall’intervallo ideale può influire sulla salute e sul benessere e quindi sul processo di crescita.

Si possono utilizzare diversi metodi, tra cui l’uso di lampade termiche, ventole e riscaldatori (centrali). In alternativa, è possibile utilizzare uno scambiatore di calore come ECO Unit, che contribuirà alla creazione di una temperatura più costante durante tutto l’anno. Contribuisce in modo significativo a ridurre la necessità di fonti di calore esterne, mantenendo ai giusti livelli la temperatura corporea dei polli da carne in crescita.
5. Prevenzione delle malattie
L’igiene deve essere presa in considerazione molto seriamente, non solo per il pollaio, ma anche per l’intero processo di alimentazione e abbeveraggio.
Infatti, tutti gli spazi e gli elementi devono essere mantenuti puliti il più possibile e privi di parassiti. Inoltre le cure preventive, come il rispetto dei programmi di vaccinazione, aiutano a prevenire le malattie più comuni nei polli da carne, mantenendoli in salute per tutta la loro vita.
Tenere in considerazione questi 5 fattori può aiutare gli allevatori di polli da carne a ottimizzare la crescita e la produttività dei propri gruppi, contribuendo alla salute e al benessere del gruppo e migliorando i risultati aziendali.
Contatta i nostri esperti di avicoltura, che sono a disposizione per fornire ulteriori consigli in base alla tua situazione specifica. Se desideri conoscere il modo in cui Vencomatic Group può contribuire al miglioramento della qualità dell’avicoltura, scarica il white paper inquadrando il QR code.

18 FOCUS - focus -
L’eccellenza genetica delle ovaiole Hy-Line determina una vitalità eccezionale e uova di qualità superiore... offrendo nel contempo una conversione allo stato dell’arte. Tutto ciò concorre a raggiungere un profi tto potenziale senza paragoni.

www.hyline.com info@hyline.com

© 2012 Hy-Line International

Una
proiezione dello sviluppo della produzione mondiale di carne avicola fino al 2031
Lo scopo di questo documento è quello di analizzare le dinamiche emergenti per la carne avicola a livello continentale e nazionale e di documentare i fattori guida sottostanti.

20 - marketing -
MARKETING
Hans-Wilhelm Windhorst L’autore è Professore Emerito all’Università di Vechta e Visiting Professor all’Università di Medicina Veterinaria di Hannover, Germania
©www.rspcaassured.org.uk
L’ultimo rapporto congiunto Prospettive agricole OCSEFAO prevede un aumento della produzione mondiale di carne, che salirà da 345,2 milioni di tonnellate nel 2022 a 377,2 milioni di tonnellate nel 2031. Su un totale di 32,0 milioni di tonnellate, 17,9 (pari al 55,9%) saranno di carne avicola, 8,1 milioni di tonnellate (25,2%) di carne suina e 4,2 milioni di tonnellate di carne bovina (13,0%). La Figura 1 mostra come i quattro principali tipi di carne si svilupperanno in modo diverso.
ranno registrare il più alto aumento assoluto (Tabella 1) e l’Africa il più alto aumento relativo del volume di produzione. In Europa, la produzione dovrebbe crescere solo di 588.000 tonnellate, pari al 2,7%. Anche in Nord America il tasso di crescita relativo sarà inferiore alla media mondiale.
Tabella 1 – Previsione di sviluppo della produzione mondiale di carne avicola tra il 2022 e il 2031 a livello di continente; dati in migliaia di tonnellate (fonte: rapporto Prospettive agricole OCSEFAO).
Figura 1 – Proiezione dello sviluppo del volume di produzione dei quattro tipi di carne tra il 2022 e il 2031 (design: A.S. Kauer sulla base dei dati del rapporto Prospettive agricole OCSE-FAO).
Nel decennio in esame il divario tra il volume di produzione di carne avicola e suina aumenterà da 15 a quasi 25 milioni di tonnellate.
Notevoli dinamiche in Asia e America Latina
Un’analisi dettagliata dello sviluppo della produzione a livello continentale rivela che l’Asia e l’America Latina fa-
La Figura 2 illustra in modo impressionante anche la tendenza generale verso l’aumento della produzione in tutti i continenti, con un ruolo eccezionale dell’Asia.

La tendenza riflette anche il cambiamento nella produzione tra carne rossa e bianca che è stato osservato per diversi decenni (cfr. Windhorst 2021), che, tuttavia, si è sviluppato in modo diverso nei continenti. Il favorevole tasso di conversione dei mangimi del pollame, in particolare dei polli da carne, è un aspetto che sta diventando sempre più importante per quanto riguarda l’aumento dei costi dei mangimi. Inoltre non esistono barriere religiose

21 - maggio 2023MARKETING
[mil. tonnellate ] 0 40 80 120 160 2022 2025 2028 2031 Ovini Bovini
Suini Avicoli
Continente 2022 2031 Variazione assoluta relativa (%) Africa Asia Europa Nord America Centro e Sud America Oceania 6.954 52.579 22.081 24.272 28.371 1.671 8.912 63.108 22.668 25.969 31.315 1.872 1.963 10.529 588 1.692 2.944 201 28,2 20,0 2,7 7,0 10,4 12,0 Mondo 135.929 153.844 17.921 13,2
al consumo di carne bianca, il che spiega il rapido aumento della produzione, in particolare nei paesi islamici e indù con alti tassi di crescita della popolazione e un reddito pro capite in crescita.
Un confronto tra le quote dei continenti nella crescita della produzione globale mostra che l’Asia sarà il leader indiscusso con il 58,8%, seguita dall’America Latina con
il 16,4% e dall’Africa con l’11,0%. L’Europa e l’America del Nord rimarranno molto indietro, rispettivamente al 2,7% e al 10,4%. Oltre alla popolazione in lenta crescita, un importante fattore di guida è il consumo pro capite già molto elevato, che consente solo piccoli tassi di aumento.
Le diverse dinamiche previste nello sviluppo della produzione avranno un impatto sulle quote dei singoli continenti nel volume di produzione globale. Come si evince dalla Figura 3, l’Asia (+2,3%) e l’Africa (+0,7%) possono incrementare il loro contributo alla produzione globale, mentre l’Europa (-1,5%), il Nord America (-1,0%) e l’America Latina (-0,5%) dovranno accettare delle perdite. Uno sguardo più attento allo sviluppo a livello nazionale mostrerà quali Paesi possono beneficiare delle dinamiche emergenti e quali tendono a perdere importanza.
Figura 2 – Previsione di sviluppo della produzione mondiale di carne avicola tra il 2022 e il 2031 a livello di continente (design: A.S. Kauer sulla base dei dati del rapporto Prospettive agricole OCSE-FAO).
Il rapporto congiunto Prospettive agricole OCSEFAO fornisce solo i dati relativi allo sviluppo complessivo nell’UE (27). Il volume di produzione dovrebbe aumentare da 13,6 milioni di tonnellate nel 2022 a 13,9 milioni di tonnellate (2,0%), ben al di sotto del 2,7% previsto per l’Europa. Se fossero stati considerati gli Stati membri dell’UE, la Polonia sarebbe stata ottava e la Germania quindicesima tra i 15 leader nel 2022. Nel 2031 è probabile che solo la Polonia rimanga nel primo gruppo, a causa dei tassi di crescita più bassi in Germania rispetto a quelli di diversi Paesi in via di sviluppo.
Figura 3 – Contributo dei continenti nella produzione mondiale di carne avicola tra il 2022 e il 2031 (design: A.S. Kauer sulla base dei dati del rapporto Prospettive agricole OCSE-FAO).
I Paesi in via di sviluppo1 determineranno lo sviluppo futuro
Un’analisi dell'evoluzione prevista della produzione in funzione del livello di sviluppo dei Paesi mostra che quelli in via di sviluppo saranno la forza trainante nel decennio in corso (Figura 4).
La quota dei Paesi sviluppati nella produzione mondiale di carne di pollame scenderà dal 38,9% al 36,3%, mentre quella dei Paesi in via di sviluppo aumenterà dal 61,1% al 63,7%. Nel 2022, il divario tra i due gruppi era di 30,3 milioni di tonnellate, mentre aumenterà a 42,2 milioni di tonnellate (quasi il 40%) nel 2031.
22 - marketingMARKETING
Totale: 135,9 mil. t 1,2% 20,9% 17,9% 16,2% 38,7% 5,1% 2022 Totale: 153,9 mil. t 1,2% 20,4% 16,9% 14,7% 41,0% 5,8% 2031 Africa Asia Europa Nord America Centro e Sud America Oceania
Africa Asia Europa Nord America Centro e Sud America Oceania [mil. tonnellate] 0 17,5 35 52,5 70 2022 2025 2028 2031
1 N el rapporto Prospettive Agricole OCSE-FAO i Paesi emergenti sono inclusi nel gruppo dei Paesi in via di sviluppo.
Figura 4 – Previsione di sviluppo della produzione mondiale di carne avicola a livello nazionale (design: A.S. Kauer sulla base dei dati del rapporto Prospettive agricole OCSE-FAO).


Questi dati riflettono l'incremento demografico previsto: tra il 2022 e il 2031 la popolazione globale aumenterà da 8 miliardi a 8,4 o 8,5 miliardi. Asia e Africa saranno i continenti con la più alta crescita demografica: per il decennio in corso si prevede un aumento annuo tra 65 milioni e 68 milioni di euro.
Nel 2031 l’aumento previsto di 68 milioni sarà ripartito tra Africa (37 milioni) e Asia (26 milioni); per le Americhe si prevede un aumento di circa 6 milioni, mentre in Europa la popolazione diminuirà di 1,1 milioni.
Tabella 2 – Previsione di sviluppo della produzione di carne avicola in 15 Paesi leader, con esclusione dei membri EU(27); dati in migliaia di tonnellate (fonte: rapporto Prospettive agricole OCSE-FAO).
PROGETTUALITA’ • PROFESSIONALITA’ • AFFIDABILITA’ DA OLTRE 50 ANNI
I sistemi VDL Jansen sono noti per la loro qualità e affidabilità. Vengono proposte varie soluzioni, tra cui sistemi a voliera per ovaiole commerciali e svezzamento pollastre, nidi per ovaiole commerciali e riproduttori.






23 - maggio 2023MARKETING
[mil. t]
0 25 50 75 100 2022 2025 2028 2031
Paesi sviluppati Lineare (Paesi sviluppati) Paesi in via di sviluppo
Lineari (Paesi in via di sviluppo)
Paese 2022 2031 Variazione assoluto relativo (%) Cina* USA Brasile* India* Indonesia* Russia Messico* Turchia* Iran Pakistan Sud Africa* Thailandia* Perù Colombia Vietnam 21.279 22.797 14.818 4.301 4.090 4.589 3.705 2.347 2.306 1.942 1.923 1.892 1.807 1.759 1.565 24.448 24.321 15.588 6.379 4.931 4.821 4.068 2.973 2.865 2.591 2.300 2.197 2.301 2.212 1.924 3.169 1.524 770 2.078 841 232 363 626 559 649 377 305 494 453 359 14,9 6,7 5,2 48,3 20,6 5,1 9,8 26,7 24,2 33,4 19,6 16,1 27,3 25,8 22,9 15 Paesi 91.120 103.919 12.799 14,0 Mondo 135.929 153.850 17.921 13,2
*Paesi emergenti
La Tabella 2 documenta lo sviluppo della produzione previsto a livello nazionale. Dei 15 Paesi considerati, cinque sono in via di sviluppo, otto sono Paesi emergenti e solo due sono sviluppati.
La Tabella 3 elenca i sei Paesi con i più alti aumenti assoluti nella produzione di carne avicola tra il 2022 e il 2031: essi rappresenteranno il 50,4% della crescita della produzione mondiale. La classifica dei Paesi con il più alto tasso di crescita relativa differisce da quella con il più alto aumento assoluto. Vale la pena notare che quattro

Tabella 3 – I sei Paesi con l’aspettativa di crescita assoluta e relativa più alte nella produzione di carne avicola tra il 2022 e il 2031 (fonte: calcoli dell’autore sulla base dei dati del rapporto Prospettive agricole OCSE-FAO).
dei sei Paesi leader con la più alta crescita assoluta si troveranno in Asia, così come anche quattro con i più alti tassi di crescita relativi.
Le diverse dinamiche dei vari Paesi cambieranno le rispettive quote nella produzione globale e la loro classifica (Figura 5). La Cina sostituirà gli Stati Uniti al primo posto e sarà il Paese con il più alto volume di produzione nel 2031. Gli Stati Uniti, il Brasile, la Russia e il Messico
24 - marketingMARKETING
Paese Crescita assoluta (1,000 t) Paese Crescita relativa (%) Cina India USA Indonesia Brasile Pakistan 3.169 2.078 1.524 841 770 649 India Pakistan Perù Turchia Colombia Iran 48,3 33,4 27,2 26,7 25,8 24,2 6 Paesi 9.021 -Totale: 135,9 mil. t 39,5% 1,4% 1,7% 1,7% 2,7% 3,0% 3,2% 3,4% 10,9% 15,7% 16,8% 2022 Totale: 153,9 mil. t 39,7% 1,7% 1,9%1,9% 2,6% 3,2% 4,1% 3,1% 10,1% 15,9% 15,8% 2031 USA Cina Brasile Russia India Indonesia Messico Turchia Iran Pakistan Altri
Figura 5 – Contributo dei dieci Paesi leader alla produzione mondiale di carne avicola tra il 2022 e il 2031 (design: A.S. Kauer sulla base dei dati del rapporto Prospettive agricole OCSE-FAO).
perderanno quote, mentre i Paesi asiatici saranno leader nel settore, riuscendo ad aumentare significativamente la loro quota nella produzione mondiale (l’India da sola arriverò allo 0,9%). Nel 2031 India e Indonesia si classificheranno davanti alla Russia, che scenderà al sesto posto. Questi cambiamenti documentano ancora una volta il ruolo eccezionale che i Paesi asiatici svolgeranno nel futuro sviluppo della produzione mondiale di carne avicola.
La carne alternativa al pollame diventerà un concorrente?
Per quanto riguarda lo sviluppo dinamico nella produzione di succedanei vegetali della carne e l’emergente possibilità di produrre carne da colture cellulari e di introdurla sul mercato, sorge la domanda su quale impatto questi fenomeni possano avere sulla produzione convenzionale di carne. Nel 2021 il volume delle vendite globali di sostituti della carne a base vegetale ha raggiunto 5,7 miliardi di US-$. Europa occidentale e Nord America hanno con-
“Nel 2021 il volume delle vendite globali di sostituti della carne a base vegetale ha raggiunto 5,7 miliardi di US-$. Europa occidentale e Nord America hanno contribuito con 4,7 miliardi di US-$. La carne proveniente da colture cellulari (carne avicola) è stata approvata solo a Singapore e finora non ha generato vendite significativeˮ


PANNELLO IN PLASTICA PER SISTEMA PAD


Il sistema Pad Climate LUBING è fatto completamente in plastica. Viene usato in tutte le situazioni nelle quali si necessita un sistema ad alta efficienza.
• Per il raffreddamento evaporativo dei capannoni di polli e suini.
• Eccellente capacità di raffreddamento - design brevettato.
•Facile da pulire.
•Lunga durata
•Minima perdita di pressione
•Alta resistenza agli UV
•Impermeabilità alla luce
- maggio 2023MARKETING
!lanigirO
Via Marco Polo, 33 - 35011 - Campodarsego (PD) ITALIA +39 0499202290 - lubingsystem.com - info@lubing.it
VISITA IL NOSTRO SITO
tribuito con 4,7 miliardi di US-$. La carne proveniente da colture cellulari (carne avicola) è stata approvata solo a Singapore e finora non ha generato vendite significative.
Nel complesso, i sostituti della carne rappresentavano solo lo 0,5% dei 1.071 miliardi di dollari venduti in tutto il mondo. Durante l’incontro COP27 in Egitto nel novembre 2022 aziende e organizzazioni hanno avuto l’opportunità di presentare le loro tecnologie e i prodotti in un padiglione ufficiale e di presentare argomentazioni sulla loro importanza nell’alimentazione di una popolazione mondiale in crescita. Queste attività hanno ricevuto un’ampia copertura mediatica.
L’erogazione di finanziamenti in diversi Paesi e le dichiarazioni politiche dimostrano che sono state riconosciute le opportunità offerte dall’utilizzo di queste tecnologie. Nonostante la crescente accettazione di prodotti alternativi da parte dei consumatori, però, i sostituti della carne e la carne proveniente da colture cellulari rappresenteranno solo una piccola percentuale del consumo totale di carne nel 2031. Una ragione è che per aumentare le capacità di produzione sono necessari investimenti elevati, un secondo motivo è che la carne da colture cellulari è stata approvata solo a Singapore e la tecnologia per la produzione di colture cellulari è presente negli Stati Uniti. Inoltre, ci sono ancora molti problemi tecnici da risolvere, derivanti dall’allargamento dei bioreattori per la produzione di quantità che sono di interesse per il mercato. A questo si aggiungono gli elevati costi di produzione, che si oppongono a una parità di prezzo con la carne avicola prodotta in modo convenzionale nel prevedibile futuro (cfr. Windhorst 2023).

TENDENZE DI MERCATO
INTERVISTE
NUOVI PRODOTTI
EVENTI PROFILI AZIENDALI
Una conclusione preliminare
REPORT
e le ultime novità della scienza e della tecnica sul nostro sito: zootecnica.it
La carne avicola mostrerà i più alti tassi di crescita assoluta e relativa di tutti i tipi di carne nel decennio in corso. La conversione alimentare favorevole del pollame, in particolare dei polli da carne, rispetto ai suini e ai bovini, e la mancanza di barriere religiose al consumo saranno i fattori chiave alla base delle dinamiche emergenti. Altri vantaggi includono la versatilità della carne avicola, la sua posizione nei ristoranti fast food e un prezzo più basso per i consumatori rispetto a manzo e maiale. Inoltre, il breve ricambio generazionale nell’avicoltura consente una reazione più rapida ai cambiamenti del mercato rispetto ai periodi significativamente più lunghi che sono necessari per l’allevamento di suini e bovini. I Paesi in via di sviluppo e quelli emergenti dell’Asia e dell’America Latina saranno
26 - marketingMARKETING
SULLE ULTIME NOVITÀ DEL SETTORE
www.zootecnica.it PER ESSERE AGGIORNATI
NEWS DALLE AZIENDE
i principali motori di questa crescita prevista. I Paesi industrializzati dell’Europa e del Nord America perderanno quote di mercato nonostante l’aumento della produzione a causa di una crescita lenta e persino del declino della popolazione. Il già elevato consumo pro capite non consente una rapida espansione della produzione. Tuttavia, per alcuni Paesi è probabile che sorgano opportunità di esportazione perché in molti Paesi in via di sviluppo ed emergenti la domanda di carne bianca crescerà più rapidamente della possibilità di aumentare la produzione interna.
Bibliografia e approfondimenti




OECD-FAO Agricultural Outlook 2022-2031. https://stats. oecd.org.
UN World Population Prospects 2022. https://population. un.org/wpp.
USDA Agricultural Projection to 2031. https://www.ers. usda.gov/publications/pub-details/?pubid=103309.
Windhorst, H.-W.: The Champions League of the chicken meat producing countries. In: Zootecnica International 42 (2020), nos. 7/8, p. 22-26.
Windhorst, H.-W.: The forgotten world: the chicken meat industry in the least developed countries. In: Zootecnica International 43 (2021), no. 3, p. 28-32.
Windhorst, H.-W.: The red-white-shift in global meat production. In: Zootecnica International 43 (2021), no. 5, p. 32-37.
Windhorst, H.-W.: Patterns and dynamics of global egg and poultry meat trade. Part 2: Poultry meat trade. In: Zootecnica International 44 (2022), no. 3, p. 24-27.
Windhorst, H.-W.: Patterns of the poultry industry in the MEA region: Part 2: Poultry meat production and trade.



In: Zootecnica International 44 (2022), no. 9, p. 32-35.
Windhorst, H.-W.: Dynamics and patterns of the poultry industry in the G 19 countries between 2010 and 2020.

In: Zootecnica International 44 (2022), no. 12, p. 22-27.
Windhorst, H.-W.: The revolution is taking shape. In: Fleischwirtschaft international (2023), no. 1, p. 34-39.
TECNOLOGIE AVANZATE per L’AVICOLTURA
STRUTTURE AVICOLE
Progettazione e realizzazione chiavi in mano ARCHI DISINFETTANTI
Sistemi personalizzati per la disinfezione dei mezzi in ingresso
ATTREZZATURE
Sistemi per allevamento carne e ventilazione ASSISTENZA
MAGAZZINO RICAMBI
Rivenditore per l’Italia di:
BLUE FAN
Materiale anticorrosivo
Alte prestazioni, Risparmio energetico


CENTRALINE DI CONTROLLO
Analisi, ottimizzazione e gestione automatica dell’allevamento
CAPPE RADIANTI
Sistemi di riscaldamento a infrarossi ad alta efficienza
NIDI E VOLIERE
Attrezzature per ovaiole da consumo RACCOLTA UOVA
Sistemi automatici raccolta e imballaggio uova
NIDI RIPRODUTTORI
Attrezzature per riproduttori da cova
27 - maggio 2023MARKETING
MBE srl | Via delle Fornaci 88/A, Fabriano (AN) www.mbefabriano.it | +39 0732 627167 | Facebook @MBESRL2013 | Instagram @mbe_srl
1University of Tennessee Animal Science Department,
2University of Tennessee Biosystems Engineering and Soil Science Department,
3Tennessee State University College of Agriculture
Gestione della lettiera
Una valida gestione della lettiera, prima, durante e dopo il ciclo è un fattore chiave per migliorare le performance del pollo, il suo benessere e salute. Gli allevatori capaci sanno che una buona gestione della lettiera è critica, soprattutto oggi che si alleva senza antibiotici.

Gli allevatori avicoli sanno bene che una valida gestione della lettiera inizia già dal gruppo precedente. Se si aspetta l’accasamento di un nuovo gruppo per iniziare un programma gestionale, si è già atteso troppo, e probabilmente solo il gruppo successivo trarrà beneficio dal lavoro svolto. Le
condizioni della lettiera non cambiano dal giorno alla notte, ma è necessario stare al passo con i cambiamenti: la gestione della lettiera è un processo costante, che richiede tempo e fatica da parte dell’allevatore. Fortunatamente esistono diverse opzioni che possono aiutare: ad esempio il condi-
28
Tom Tabler1, Shawn Hawkins2, Yang Zhao1, Pramir Maharjan3
TECHNICAL COLUMN - technical column -
©Popular science
zionamento della lettiera, l’asportazione della crosta e l’aerazione, metodiche che ne favoriscono una migliore gestione fra i vari gruppi.
Anche ridurre la quantità di acqua che la bagna e aumentarne la quantità che da essa evapora rappresentano metodi risolutivi efficaci.
Problemi di lettiera e di umidità
In questi tempi l'aumento dei prezzi sta causando una carenza di materiali tradizionali usati per la lettiera, come trucioli trucioli di pino, lolla di riso e di arachidi. Anche la distribuzione sul terreno può essere un problema in termini di impatto ambientale, secondo le regolamentazioni locali. Inoltre, la lettiera usata può essere fonte di prolificazione di patogeni e infettare quindi i gruppi successivi.
Negli Stati Uniti il riutilizzo della lettiera esistente è pratica frequente, ma sta diventando un problema per questi motivi:
• presenza di elevati livelli di ammoniaca nelle prime fasi della pulcinaia;
• problemi di umidità legati a lettiera bagnata e quindi di benessere degli avicoli;
• maggiori costi di energia (gas ed elettricità) per mantenere una buona qualità dell’aria;
• passaggio di patogeni da un gruppo al successivo, causa di possibile malattie.
Il fattore chiave che influenza la qualità della lettiera è l'umidità, che viene associata a diversi fattori, quali la temperatura, l’ambiente del capannone, la sua ventilazione, il livello di umidità ecc., e anche alle proprietà della lettiera stessa (materiale usato, nuovo o vecchio, profondità, umidità ecc.). La lettiera umida è un problema ben noto da almeno cento anni, che continua a rappresentare un fattore critico per il settore avicolo, nonostante lo sviluppo genetico, gli schemi di accasamento, le tecniche di ventilazione e le metodiche produttive. Determinare quale sia il livello eccessivo di umidità non è facile.
In Mississippi il livello medio di umidità della lettiera dei polli da carne si aggira sul 27%. Livelli superiori al 25% possono comprometterne la capacità di ammortizzare l’isolamento e la ritenzione idrica. Oltre il 35% si sviluppa facilmente dermatite plantare. Non esiste tuttavia un valore singolo che definisca il momento in cui iniziano i problemi, così come non c’è una singola fonte di umidità
che causi lettiera umida. Sono diversi i i fattori che ne aumentano l’umidità, tra i quali possiamo citare il materiale usato, le sue proprietà, le condizioni (umidità, friabilità, vischiosità), il tasso di deposizione degli escrementi, l'attività dei polli, l'ambiente del capannone, i programmi di ventilazione, ecc. Si stima che la quota di acqua derivante dagli escrementi vari da 1,5 a 3,2 litri/m2 /giorno; poi, con la crescita degli avicoli, aumenti fino a 100 litri/ m2 /giorno. È una quantità altissima, molto superiore alla capacità di trattenimento e assorbimento della lettiera. In questo modo si comprende facilmente l’importanza dell’evaporazione e rimozione dell'umidità tramite una corretta ventilazione.
L’ammoniaca (NH3) rappresenta uno dei principali problemi con la lettiera riutilizzata o rigirata, in particolare se essa è umida. Livelli alti di NH3 nei capannoni avicoli comportano problemi di benessere animale, prestazioni ridotte e peggioramento della salute con perdite economiche a livello di allevamento e macellazione.
La riduzione dello stress nel periodo di crescita è fondamentale per mantenere adeguati standard di benessere ed è cruciale nel diminuire il costo per chilo di carne al momento del carico. La volatilizzazione dell’ammoniaca dipende dalla temperatura, dal pH, dall’umidità e dalla movimentazione dell’aria. Si noti che l’evaporazione dipende anche dal contenuto in umidità della lettiera e dal flusso di ventilazione che le scorre sopra.
Controllo dell’umidità
Il controllo dell’umidità dipende in gran parte dalle pratiche di gestione. Ciò significa controlli regolari del sistema idrico per evitare perdite e un continuo monitoraggio della ventilazione. Regolare l’altezza degli abbeveratoi e la pressione dell’acqua con il crescere dei polli è fondamentale per prevenire sprechi di acqua e sversamenti.
Aumentare costantemente la ventilazione nel gruppo in crescita è necessario per rimuovere l’umidità della lettiera e anche una densità uniforme degli avicoli in allevamento è vitale per controllarla; ciò significa anche spostare regolarmente il gruppo da metà a tutto il capannone, uniformando la distribuzione dei soggetti dalla pulcinaia al fondo del capannone. Con l’uso di flussometri, sia nella zona pulcinaia che nel resto del capannone, si riesce a controllare l’uniformità della distribuzione. L’umidità della lettiera può essere ridotta anche con l’installazione
29 - maggio 2023TECHNICAL COLUMN
di piccoli ventilatori a soffitto, che possono funzionare costantemente oppure essere regolati dall’allevatore in base alle esigenze del momento. I ventilatori a soffitto mantengono una ventilazione leggera, movimentando l’aria senza creare spifferi o correnti, il che favorisce la rimozione della stratificazione termica nel capannone e incentiva l’asciugatura della lettiera.
È importante infine deviare l’acqua piovana lontano dai capannoni e dai pannelli; l’acqua stagnante può infatti penetrare nei pannelli e di conseguenza confluire all'interno del capannone con relativo danno della lettiera. Lo spessore della copertura dovrebbe essere almeno di 7-8 centimetri, con una distribuzione uguale in tutto il capannone, perché, se lo spessore è diverso, si creano problemi di accesso uniforme ad abbeveratoi e mangiatoie. Di solito la lettiera che si trova davanti al pannello di raffrescamento è dura e spesso umida, e ciò crea un aumento dei livelli di ammoniaca.
La qualità della lettiera non si esaurisce nel mantenerne il livello ideale di umidità, ma deve anche essere friabile e
favorire il benessere animale. Una lettiera friabile, infatti, perde più facilmente umidità e il pollo vi può razzolare comodamente ed effettuare tutte le sue attività tipiche. L’umidità invece favorisce la coesione delle particelle di lettiera, che la rendono appiccicosa. Un aumento del livello di umidità dal 20 al 30% causa un’adesione delle particelle che formano dei blocchetti, in cui l’acqua funge da legante naturale.
La ventilazione aiuta la gestione della lettiera e deve essere adeguata nelle varie stagioni e dinamiche climatiche per mantenere una corretta condizione ambientale e la giusta temperatura corporea del pollo. Tuttavia, i coltivatori spesso riducono significativamente i tassi di ventilazione in inverno per risparmiare carburante e ridurre i costi di riscaldamento. In questa stagione diminuire la ventilazione porta alla formazione di lettiera umida, aumenta i livelli di ammoniaca e mette così a rischio la salute del gruppo. La conseguenza è che vengono compromessi i parametri di benessere animale e spesso bisogna aumentare di nuovo la ventilazione per ripristinare

30 TECHNICAL COLUMN - technical column -
©Perdue-Farms
livelli accettabili di NH3, cosa che richiede di solito costi maggiori di quelli che sarebbero stati necessari per una ventilazione in grado di prevenire la formazione di umidità in eccesso.
La svolta della produzione senza antibiotici
Produrre senza antibiotici richiede un modo diverso di pensare l’allevamento del pollo: ci vuole una gestione migliore che rientri nei fondamentali dell’allevamento. Utilizzare la lettiera vecchia appare spesso la soluzione migliore da adottare.
Alcune aziende rimuovono selettivamente la lettiera da alcuni allevamenti e la spargono sulla nuova in altri prima del ciclo: ciò favorisce una buona partenza del pulcino, migliorandone il sistema immunitario, elemento fonda mentale per una produzione senza antibiotici
Negli Stati Uniti allevare senza uso di antimicrobici ha mostrato le carenze di alcuni programmi di gestione; l’u so seppure di quote minime di antibiotico ha consentito finora di coprire alcune falle gestionali. Ciò che era con siderato pulito prima dei programmi antibiotic-free, oggi non lo è più; è dunque fondamentale implementare i se guenti punti:
• avere una buona qualità di uova da schiusa;
• massima igiene negli incubatoi;
• migliorare la qualità del mangime;
• migliorare la gestione e in particolare la qualità della lettiera, dell’aria, il controllo della ventilazione, della temperatura e dell’ammoniaca.
In ogni fase e aspetto dell'allevamento debbono essere messe in atto buone pratiche gestionali, includendo soprattutto i seguenti fattori critici:
• buon programma di biosicurezza;
• buon programma di vaccinazione;
• raccolta e gestione della documentazione di buone pratiche aziendali;
• buon programma alimentare;
• mangime di buona qualità;
• adeguato programma sanitario nei riproduttori;
• pulizia degli incubatoi, delle scatole dei pulcini e dei camion di consegna;
• pratiche aziendali dirette alla qualità della lettiera, ai livelli giusti di ammoniaca, di temperatura, ventilazione e umidità.
SEMPRE AGGIORNATI SULLE ULTIME NOVITA’ del settore avicolo con
Zootecnica International offre un’ampia panoramica sull’avicoltura con notizie, approfondimenti, interviste, tendenze di mercato e articoli tecnici e scientifici. Edita in tre lingue, italiano, russo e inglese, è diretta a tutti gli operatori della filiera avicola: allevatori, produttori di uova, case di selezione, incubatoi, mangimifici, aziende di lavorazione e trasformazione di carne avicola e di uova.
zootecnica.it

31 - maggio 2023TECHNICAL COLUMN
I programmi di allevamento senza uso di antibiotici richiedono:
• densità di allevamento ottimale;
• buona gestione della lettiera;
• ambiente di accasamento ideale;
• buon mangime prestarter;
• buona qualità dell’acqua di bevanda e programmi di pulizia e sanificazione delle linee idriche.
La gestione della lettiera in inverno
Diversi fattori rendono problematica la gestione della lettiera in inverno: l’aria fredda esterna; la necessità di mantenere la temperatura della pulcinaia sui 35 °C; distribuire uniformemente il flusso di aria per avere la stessa temperatura ovunque; il costo del gas. Anche in questo caso l’umidità è un fattore chiave nel salvaguardare la qualità della lettiera. Ma da dove proviene questa umidità? I polli consumano circa due chili di acqua per ogni chilo di mangime; l’80% di questa acqua viene immessa in ambiente in forma di escrementi e respirazione. Un’altra possibile fonte di umidità è data dall’attività delle cappe riscaldanti che, per ogni chilo di gas consumato, producono circa 600 gr di acqua: tale umidità va controllata tramite la ventilazione, la cui quota necessaria varia quasi costantemente. Il tasso di ventilazione deve essere quello necessario per gestire l’ammoniaca a livelli inferiori alle 25 ppm, con un’umidità che vari dal 50 al 70%. Aspettare fino a quando la lettiera diventa appiccicosa per poi ventilare è inutile: a quel punto non si riuscirà più, con la sola ventilazione, a ritornare alla situazione precedente.
Impilamento e ventilazione
Si tratta di una pratica gestionale utile e poco costosa che riduce la carica dei patogeni che si crea nella lettiera vecchia. Non si tratta di un compostaggio, perché le pile di lettiera non restano cosi a lungo da dare inizio al compostaggio ma, se eseguito correttamente, si instaura un processo termico capace di uccidere i patogeni presenti, inattivandoli.
L’umidità della lettiera non deve superare il 25-30%, altrimenti non si attiva il processo termico e si sono sprecati tempo e carburante. Occorre tempo anche per usare correttamente la strumentazione per questa procedura, per fare partire e funzionare il processo: quindi almeno più di 10 giorni, tra un gruppo e l’altro, altrimenti il rischio è di fare un lavoro inutile e poco pulito. Comunque, se lo si fa correttamente, e con il livello di umidità adeguato per arrivare alle temperature previste, molti dei patogeni presenti sulla lettiera verranno eliminati. In base al livello di umidità, sarà necessario lasciarla incrostata più a lungo per instaurare il processo termico. Dopo il processo, si deve tenere la lettiera per 3-4 giorni a seccare e raffreddare prima di distribuirla, altrimenti la quota di ammoniaca prodotta supererà la sua capacità ammendante e non farà il suo lavoro. Una lettiera più profonda di 15 cm è difficile da gestire, perché troppo voluminosa: per tale pratica l'ideale è uno strato con una profondità che vari da 8 a 15 cm.
Conclusioni
L’umidità della lettiera è sempre problematica per gli allevamenti avicoli; essa crea varie difficoltà quali una maggiore carica batterica, alti livelli di ammoniaca e problemi ai plantari dei soggetti.
Produrre senza uso di antibiotici richiede una corretta gestione d'allevamento; condizioni di scarsa qualità della lettiera sono stressanti e causano ai polli vari problemi di benessere. Togliere la superficie incrostata della lettiera, condizionarla e impilarla sono opzioni che consentono all’allevatore di migliorare notevolmente le condizioni degli avicoli.
La bibliografia è disponibile su richiesta Dagli atti della Midwest Poultry Federation Convention - 2022
32 TECHNICAL COLUMN - technical column -
COMPETENZA & PROFESSIONALITÀ
Proteggere i tuoi animali protegge il tuo business.

I prodotti, i servizi e l’esperienza di Elanco possono aiutarti a migliorare e consolidare il tuo successo nel settore avicolo, un mercato in continua evoluzione. Elanco e la barra diagonale sono marchi registrati di Elanco o sue affiliate. ©2022 Elanco. PM-IT- 22-0032

33 - maggio 2023TECHNICAL COLUMN Poultry
Stress da caldo: il livello di vitamina E e la fonte di zinco contano
Lo zinco e la vitamina E sono antiossidanti fondamentali, che proteggono l’intestino e sostengono la crescita e la salute dei broiler in condizioni di stress da caldo. I risultati migliori si ottengono fornendoli durante i primi giorni di vita; ricerche recenti hanno dimostrato che dosaggi elevati non sempre danno risultati migliori.

Il prezzo elevato dei mangimi, da solo, costituisce una sfida enorme da superare. Tuttavia, quando i produttori affrontano sfide ulteriori, come ad esempio lo stress da caldo, viene esercitata una pressione ancora maggiore sul controllo dell’efficienza alimentare, sulle performance degli animali e sulla redditività dell’allevamento.
La salute intestinale svolge un ruolo importante nel rendere i volatili più resistenti, più sani e in linea con le aspettative durante tutte le sfide che affrontano, compreso lo stress da caldo. Tanto prima viene favorita la maturazione intestinale, tanto migliori saranno i risultati ottenibili. L’intervento precoce è fondamentale, perché lo sviluppo intestinale del pulcino è
34
MANAGEMENT - management -
Dr. Cibele Torres, Nutrizionista di pollame presso Zinpro corporation
rapido nelle prime fasi della vita. Nei primi 3 giorni dopo la schiusa l’area di assorbimento dei nutrienti dell’intestino aumenta del 70% (aumento della lunghezza dei villi).
Ciò è fondamentale, perché il pulcino deve adattarsi rapidamente da una dieta basata sui lipidi (quelli del sacco vitellino) a una dieta basata su carboidrati solidi/proteine. Lo sviluppo intestinale è completo entro 10 giorni e il microbioma dell’intestino maturo si consolida all’età di circa 17 giorni.
Zinco e vitamina E
Nel corso degli anni il settore ha capito come determinare e misurare la “salute intestinale”, nonché come promuoverla con la nutrizione, con additivi alimentari, come ad esempio lo zinco e la vitamina E.
Sia lo zinco che la vitamina E sono antiossidanti fondamentali che proteggono l’intestino mediante diverse modalità. Tuttavia, non tutte le fonti di zinco presenti sul mercato sono identiche e non tutte garantiscono le medesime performance. Pertanto, il tipo di zinco utilizzato nella dieta influisce sul livello realmente disponibile di questo elemento. Sebbene le risposte allo zinco e alla vitamina E nella dieta siano state studiate a diverse temperature ambientali, non ci risulta che allo stato attuale le interazioni di fonti diverse di zinco e di vitamina E siano state studiate in condizioni di stress da caldo nei broiler.
Per questa ragione, uno studio condotto da De Grande et al. (2021), pubblicato sulla rivista Journal of Animal Physiology and Animal Nutrition, ha osservato i diversi livelli di vitamina E in associazione a diverse fonti di zinco.

L’esperimento ha considerato due fonti di zinco: 60 mg/ kg di Zn come ZnSO4 oppure 60 mg/kg di Zn come complessi zinco aminoacido1 (Zinpro Availa Zn nel prosieguo ZnAA), associati a due livelli di vitamina E (50 o 100 UI/ kg). Le performance sono state misurate dal giorno 0 al giorno 36. Dal giorno 28 al giorno 36 (periodo di finissaggio), tutti i broiler sono stati sottoposti a temperature elevate cicliche croniche (23 °C ± 2 °C e Umidità Relativa 55-65% per 6 ore al giorno).
Di più non vuol dire sempre meglio
Ci si potrebbe aspettare che fornire 100 UI di vitamina E dopo la schiusa apporti benefici maggiori rispetto al dosaggio inferiore utilizzato in questo studio (50 UI),
considerando che, durante la crescita embrionale, l’embrione consuma tutte le vitamine e gli oligoelementi per sostenere la propria crescita. Tuttavia questo studio ha dimostrato che all’età di 10 giorni, il peso vivo maggiore si otteneva quando si utilizzavano ZnAA e 50 UI/kg di vitamina E (Figura 1).
lo stress da caldo, all’età di 36 giorni.
Con ogni probabilità, questo risultato positivo è dovuto al migliore sviluppo intestinale dopo la schiusa, con un aumento della lunghezza dei villi, che si traduce in un migliore assorbimento dei nutrienti. Questi risultati sono
35 - maggio 2023MANAGEMENT
1 Z inpro® Availa® Zn, prodotto Zinpro® Performance
Minerals®
50 IU VitE100 IU VitE ZnSO4 ZnAA 50 IU VitE100 IU VitE Peso vivo a 35 giorni 2800 2750 2700 2650
Figura 1 – ZnAA in associazione a un dosaggio inferiore di vitamina E ha migliorato il peso vivo durante la fase iniziale della crescita, all’età di 10 giorni, e questo effetto è continuato durante
Annatachja De Grande ha ottenuto il Dottorato di Ricerca presso l’Università di Ghent, in Belgio, dove si è concentrata sugli effetti delle fonti di zinco nella dieta, sulla crescita e sulla salute intestinale nei broiler. Nel 2021, Da Grande et al. hanno pubblicato nuove scoperte, come discusso nel presente articolo. Al momento svolge l’attività di ricercatrice post-dottorale presso ILVO (Istituto di Ricerca per l’Agricoltura, l’Ittica e l’Alimentazione delle Fiandre).
Spiega De Grande: “Durante lo stress da caldo, i broiler subiscono un aumento del fabbisogno di diversi nutrienti e oligoelementi. Ciò impone che gli allevamenti si adattino e che il nutrizionista modifichi la formulazione quando si prevede un aumento della temperatura. Al contempo, tuttavia, non è auspicabile che la dieta diventi più costosa del necessario e i nutrienti supplementari devono essere forniti soltanto quando l’animale ne ha davvero bisogno.
Nelle nostre esperienze, abbiamo dimostrato che antiossidanti forti come lo zinco e la vitamina E dovrebbero assolutamente essere inclusi nella ‘dieta estiva’, dal momento che svolgono un ruolo importante nella salute intestinale e nella riduzione dei danni ossidativi nel tessuto muscolare. L’impiego di zinco in complessi zinco-aminoacido aumenta la disponibilità e la captazione dell’oligoelemento, traducendosi anche in una riduzione della perdita di gocciolamento della carne. Questo è uno dei parametri più importanti per la qualità della carne. Inoltre, si migliorano crescita e performance, grazie alla migliore salute intestinale e al maggiore assorbimento dei nutrienti a livello intestinale. Sorprendentemente, questi risultati sono stati raggiunti in associazione al livello minore di vitamina E, cosa che non ci aspettavamo affatto, ma che rappresenta una piacevole sorpresa in questi tempi caratterizzati dai prezzi elevati dei mangimi.”
stati confermati anche in studi precedenti e sono importanti, dato che dimostrano i benefici della modulazione dell’intestino in uno stadio precoce. Questa differenza positiva è continuata fino al giorno 28, quando è stato applicato il modello dello stress da caldo, che si riflette in un accrescimento ponderale quotidiano e in un apporto alimentare quotidiano più elevati e in un migliore indice di conversione alimentare (FCR) per l’intero periodo (Figura 2).
2 – L’FCR per l’intero periodo era ottimale quando ZnAA veniva usato in associazione al dosaggio inferiore di vitamina E.
Questo effetto non è stato riscontrato con un livello di vitamina E di 100 UI/kg, confermando che un tasso di inclusione maggiore della vitamina E in queste circostanze non è necessario.
Sviluppo intestinale iniziale
A prescindere dal livello di vitamina E, gli avicoli nutriti con una dieta integrata con ZnAA avevano villi più lunghi e un rapporto più elevato tra lunghezza dei villi e profondità delle cripte nelle sezioni del duodeno rispetto ai volatili nutriti con una dieta integrata con ZnSO4 i giorni 10, 28 e 36. I risultati riscontrati al giorno 10 sono particolarmente importanti, perché in questo stadio l’intestino si sta sviluppando.
Un aumento della lunghezza dei villi si traduce in un aumento della superficie intestinale, che è direttamente proporzionale all’efficienza digestiva e di assorbimento, pertanto anche nell’efficienza della conversione alimentare. Ciò può spiegare, in parte, gli effetti positivi di ZnAA sui parametri delle performance. Uno degli effetti principali dello zinco (ZnAA) è stato rilevato anche per l’infil-
36 MANAGEMENT - management -
1.525 1.52 1.515 1.51 1,505 1,5 1,495 1.49 1,485 50 IU VitE100 IU VitE ZnSO4 ZnAA 50 IU VitE100 IU VitE
Indice di conversione alimentare tra 0 e 36 giorni
Figura
trazione di linfociti T CD3+ nelle sezioni del duodeno il giorno 36, con un’infiltrazione minore di linfociti T CD3+ per gli avicoli nutriti con una dieta integrata con ZnAA rispetto a ZnSO4. La diminuzione dell’infiltrazione di linfociti T CD3+ era già stata rilevata al giorno 10 usando ZnAA e indica una diminuzione della stimolazione del sistema immunitario del tratto intestinale.
Lo studio ha osservato anche l’ovotransferrina, un marcatore di insufficienza della barriera intestinale nei broiler, che può essere utilizzato per valutare l’efficacia degli additivi o delle strategie che riducono i danni intestinali. Tanto minore è il livello di ovotransferrina, tanto minori sono i danni alla salute intestinale.


Per entrambi i livelli di vitamina E, l’impiego di ZnAA si è tradotto in una minore concentrazione di ovotransferrina nel contenuto dell’ileo (μg/g) rispetto a ZnSO4 (al giorno 36). Ulteriori dati hanno dimostrato che i gruppi alimentati con ZnAA rispetto a quelli con ZnSO4 vedevano anche l’aumento della produzione di carne di petto del 3,1% e la riduzione della perdita di gocciolamento a 24 ore del 25%.
VITADI Calcium
Conclusione
Le performance e la resilienza contro lo stress da caldo possono essere migliorati mediante integrazione di zinco nella forma di ZnAA utilizzata in questo studio e di un livello di vitamina E pari a 50 UI/kg in una fase precoce della vita, quando si sviluppano l’intestino e il suo microbioma.
Fornire lo zinco in questa forma si traduce in un’influenza positiva sullo sviluppo dell’intestino e del microbioma, pertanto promuove la crescita e, cosa ancora più importante, prepara l’animale alle sfide future, come ad esempio lo stress da caldo, mantenendo la qualità e la produzione della carne del petto quando ha luogo stress da caldo.
È interessante notare che, nelle condizioni di questo studio, gli effetti positivi sulle performance non si sono verificati quando la vitamina E è stata integrata nella misura di 100 UI/kg nel mangime, ma con 50 UI/kg, con conseguente beneficio economico.
Mangime Complementare avicolo
10% di calcio sia in forma organica che vitamine D3 e E
Supporta la qualità dell’uovo e il corretto processo grazie alla sinergia tra calcio
Anche in periodi di alte temperature!
Formulazione idrosolubile senza residui
ascor.vetoquinol.it
37 - maggio 2023MANAGEMENT
1 Poultry Research Foundation within The University of Sydney, Brownlow Hill NSW 2570, Australia
Confronto tra diete a base frumento e sorgo con due livelli di proteina grezza ed effetti sulle performance del pollo
Questo studio ha paragonato performance di crescita e tratti della carcassa in polli alimentati con dieta a base frumento o sorgo, con due concentrazioni diverse di proteina grezza (CP), a 170 e 210 g/kg, dai 14 ai 35 giorni di vita, con un fattore di trattamento di 2 x 2.
Introduzione
Frumento e sorgo sono due delle granaglie usate in Australia nelle diete del pollo, ma il frumento è più usato ed è anche considerato migliore del sorgo. L’industria avicola locale potrebbe vedere una richiesta di
aumento di produzione fino al 60% entro il 2050, quindi occorre mettere in campo strategie per una produzione sostenibile, anticipando così la domanda. La riduzione della proteina grezza (CP) nel pollo potrebbe essere uno dei fattori principali nella ricerca di una produzione sostenibile. Diete a CP
 S.P. Macelline1, P.V. Chrystal1, M. Toghyani1, S. Greenhalgh1, P.H. Selle1 e S.Y. Liu1
S.P. Macelline1, P.V. Chrystal1, M. Toghyani1, S. Greenhalgh1, P.H. Selle1 e S.Y. Liu1
38 - nutrizionisticaNUTRIZIONISTICA
ridotta hanno il potenziale di abbassare la escrezione di azoto e le emissioni di ammoniaca, aumentando la qualità della lettiera e il benessere del pollo, riducendo anche la dipendenza dall’importazione di soia. Le performance del pollo, però, sono spesso compromesse dalla riduzione della CP e le risposte della crescita alle proteine delle due granaglie non è nota. In alcuni studi diete a bassa proteina deprimono le performance del pollo, mentre in altri, in quelle a base mais, danno risposte soddisfacenti. La struttura delle proteine e le loro proprietà funzionali sono simili in mais e sorgo e questo contiene anche meno polisaccaridi non amidacei insolubili, ma avrebbe un tasso di digestione relativamente inferiore al frumento. La presente prova è stata disegnata per paragonare diete a base frumento o sorgo in un contesto ipoproteico.


Materiali e metodi
La prova è stata effettuata seguendo le linee guida del Comitato Etico Animale dell’Università di Sydney. 382 maschi controsessi Ross 308 sono stati distribuiti a caso in 28 box a terra, con 14 capi ciascuno e 7 repliche per trattamento, dai 14 ai 35 giorni di età. Prima era somministrata una dieta commerciale starter. Si sono quindi formulate 4 diete (Tabella 1), rispettivamente con frumento o sorgo, al 17 o 21% di proteina (con xylanasi e fitasi). Tutte le diete avevano 13MJ /kg di energia e un tasso ideale di amminoacidi (AA), basato su 11 gr/kg di Lisina digeribile. Le performance di crescita, il peso del pannello lipidico addominale e i tratti della carcassa erano determinati da 14 a 35 giorni dopo la schiusa. Si è usato JMP Pro 14 per effettuare le analisi della varianza considerando il 5% di probabilità come significativo.
Risultati
I risultati di questo confronto sono evidenziati nella Tabella 2, dove le performance di crescita totali hanno superato gli obiettivi del 2019 Aviagen per Ross 308 del 18% per la crescita, del 6,5% per il consumo alimentare e del 9,45% per la conversione. La riduzione nel mangime di CP ha compromesso la crescita del 4,61% (2232 rispetto a 2129 gr/ capo; P<0,001), il consumo del 2,72% (3157 rispetto a 3071 grammi/ capo; P=0,031). Le diete a base sorgo hanno supportato pesi maggiori rispetto a quelle a base frumento del 4,89% (2232 rispetto a 2129 grammi/capo; P=0,002). È stata osservato un’interazione significativa tra i trattamenti per conversione (FCR) nei polli alimentati con 21% CP, in cui entrambe le diete mostravano tassi di conversione statisticamente simili. Invece, con diete ipoproteiche (170 gr/kg CP) quella a base sorgo ha dato una conversione rispetto al frumento migliore del 4,90% (1437 rispetto a 1511). Pertanto, la riduzione proteica da 210 a 170 gr/kg aumentava la conversione nelle diete a base sorgo e frumento rispettivamente dell’8,94 e del 4,94%. La riduzione delle proteine ha aumentato il peso relativo del pannello adiposo del 16,7% (10,35 rispetto a 8,34 gr/
Raccolta delle uova dal nido centrale!
Le uova vengono raccolte automaticamente.
Eccellente veduta su ogni piano!
I nastri della pollina stretti garantiscono un ottimo scorrimento!
La profondità dell’impianto fino al centro è quanto un braccio!
Griglia di appoggio accessibile!
Nidi che garantiscono il benessere degli animali!
Essiccazione della pollina su richiesta del cliente!
- maggio 2023 - 39 NUTRIZIONISTICA
ORIGINAL ATTREZZATURE AVICOLE ®
»VARIA CON NIDO CENTRALE« PRODUTTORE DI ATTREZZATURE AVICOLE DAL 1961!
D-47665 Sonsbeck/Germany • Dassendaler Weg 13 Telefon +49 (0) 2838 912-0 • Fax: +49 (0) 2838 2791 www.specht-tenelsen.de • info@specht-tenelsen.de Carmen Lanzellotti +49 02838 912 0 lanzellotti@specht-tenelsen.de Hans Theo Ten Elsen GSM: +49.173-8 79 65 82 GmbH & Co. KG
kg/capo; P=0,010) e le diete a base sorgo hanno generato un peso del pannello adiposo maggiore rispetto al frumento del 31,8% (10,99 rispetto a 8,34 gr/ kg/capo; P<0,001). La riduzione di CP ha generato un peso del petto inferiore del 4,82% (228 rispetto a 217 gr/capo/kg; P<0,001) e le diete a base frumento hanno dato pesi del petto maggiori del sorgo dell’8,41% (232 rispetto a 214 gr/ kg/capo; P=0,004). Il peso delle cosce e delle sovracosce, invece, non è stato influenzato dalla dieta.
Discussione
L’interazione tra la proteina nel mangime e la conversione ha mostrato un vantaggio per il sorgo del 4,9%, con proteina al 17%, e ciò suggerisce che il sorgo sia superiore al frumento con basso livello proteico. Però il sorgo ha anche causato un aumento del 42,1% del pannello adiposo rispetto al pollo, con 17% CP, il che è svantaggioso. Questi risultati rappresentano un enigma nella formulazione di diete ipopoteiche nel pollo.
In diete a ridotta CP, il frumento pare avere minore propensione nell’aumentare il grasso addominale e per estensione tutta la deposizione di grasso, rispetto al mais e, in studi recenti, anche al sorgo. È probabile che il tasso di digestione dell’amido del frumento sia più veloce di quello del mais o del sorgo, come si è visto in prove sia in vitro che in vivo Pare che la digeribilità più lenta degli amidi di mais e sorgo e l’assunzione intestinale del glucosio più lenta e graduale promuovano la deposizione lipidica, grazie a una neolipogenesi. L’eccesso di glucosio potrebbe essere infatti immagazzinato come glicogeno nel fegato, ma la capacità delle specie avicole di immagazzinare glicogeno nel muscolo è limitata: quindi, una volta che le riserve di glicogeno sono state saturate, il glucosio rimanente viene trasformato in grasso tramite neolipogenesi a livello epatico. Invece, il glucosio derivato dall’amido del frumento, rapidamente digeribile, può essere usato meglio, grazie a un’ossidazione diretta.
Le diete a base frumento, che contenevano 170 gr/kg CP, avevano sostanzialmente più amminoacidi (51,4 grammi rispetto a 37,2 gr/kg) rispetto alle corrispondenti a base sorgo. La
40 - nutrizionisticaNUTRIZIONISTICA
Ingredienti (gr/kg) 210 g/kg proteina grezza 170 g/kg proteina grezza frumento sorgo frumento sorgo Frumento 674 - 877Sorgo - 624 - 789 Pannello soia 225 275 - 102 Olio soia 43.9 45.1 12.3 19.6 l-lisina HCl 4.20 3.55 10.9 8.72 d,l-metionina 2.68 3.21 4.31 4.66 l-treonina 1.68 1.35 4.53 3.60 l-triptofano - - 0.65 0.24 l-valina 0.90 0.50 4.30 3.17 l-arginina 0.69 0.56 6.77 5.52 l-istidina - 1.25 1.04 l-tirosina - - 2.14 0.59 l-isoleucina 0.44 0.13 3.82 2.82 l-leucina - 4.84l-fenilalanina - - 2.53 1.26 Glicina 0.13 0.98 5.57 5.63 Altri ingredienti 46.9 42.8 56.7 51.8 Amminoacidi totali non legati 10.7 10.3 51.4 37.2 Specifiche nutrienti Energia (MJ/kg) 13.0 13.0 13.0 13.0 Proteina grezza 210 207 170 170 Amido 421 399 546 503 Grasso 61.4 72.5 30.5 50.4 Calcio 8.70 8.70 8.70 8.70 P disponibile 4.35 4.35 4.35 4.35 SID lisina 11.0 11.0 11.0 11.0 SID metionina 5.21 5.77 5.89 6.45 SID treonina 7.26 7.26 7.26 7.26
Tabella 1 – Composizione e specifica dei nutrienti delle diete sperimentali.







- maggio 2023 - 41 1969 1969 distributoreperl’Italia distributore per l’Italia distributoreperl ’Italia
abc Medie tra colonne che non hanno un suffisso comune sono significativamente differenti a livelli di probabilità del 5%.
F ee d c on version ratio
8162432404856
Non-bound amino acid inclusions (g/kg)
Figura 1 – Correlazione quadratica (r=0.882; P<0.001) tra inclusione di amminoacidi non legati nella dieta e conversione FCR nel pollo y = 1.383 - 0.001*NBAA + 0.00007263*NBAA 2
genesi di questa differenza derivava semplicemente dal fatto che il contenuto proteico del frumento superava quello del sorgo. Gli AA non legati vengono assorbiti più rapidamente rispetto a quelli legati alle proteine, e ciò potrebbe alterare l’equilibrio amminoacidico post enterico, dando luogo a una deaminazione dell’eccesso di aminoacidi e alla escrezione di acido urico, processo che richiede energia. L’equilibrio tra AA legati e liberi, nel caso di diete ipoproteiche, può essere fondamentale, come suggerito da diversi studiosi, soprattutto quando AA non legati in eccesso vengono inclusi al mangime e compromettono le performance. In questa prova, ad esempio, gli AA dietetici non legati hanno compromesso l’FCR in modo quadratico, come indicato in Figura 1
Conclusioni
Le risposte del pollo a diete a base frumento o sorgo con livelli proteici del 17% di CP sono risultate divergenti, col sorgo che ha dato maggiore efficienza e migliore conversione, ma, in modo paradossale, anche una maggiore deposizione lipidica. In questa e in altre simili prove l’influenza delle granaglie usate come base del mangime ipoproteico ha, nel pollo, notevole importanza. La genesi di queste differenze tra granaglie pare correlata sia alle proprietà dell’amido che delle proteine contenute in ciascuna, che dettano la richiesta dell’aggiunta di AA sintetici. Comprendere meglio entrambi questi aspetti è fondamentale per produrre mangimi ipoproteici nel pollo.
Bibliografia disponibile su richiesta Dagli atti dell’Australian Poultry Science Symposium 2022
42 - nutrizionisticaNUTRIZIONISTICA
di vita. Trattamento Performance di crescita Tratti della Carcasss Proteina grezza (g/kg) granaglie crescita (g/capo/d ì) consumo (g/capo/d ì) FCR (g/g) Cuscinetto lipidico (g/kg) fesa (g/kg) cosce (g/kg) 210 frumento 2252 3123 1.387a 8.09 238 223 sorgo 2332 3192 1.369a 9.65 225 229 170 frumento 2024 3058 1.511c 8.55 218 232 sorgo 2147 3085 1.437b 12.15 209 234 SEM 29.0 37.5 0.0122 0.526 3.3 4.8 Effetti principali: CP 210 2292b 3157b 1.378 8.87a 232b 226 170 2086a 3071a 1.474 10.35b 214a 233 Granaglie frumento 2129a 3088 1.454 8.34a 228 b 227 Sorgo 2232b 3134 1.406 10.99 b 217a 231 Significativit à (P=) Proteina grezza (CP) <0.001 0.031 <0.001 0.010 <0.001 0.160 Granaglie (FG) 0.002 0.214 0.001 <0.001 0.004 0.416 CP x FG interazione 0.464 0.585 0.033 0.065 0.528 0.626
Tabella 2 – Performance di crescita e tratti della carcassa da 14 a 35 gg
1.3 1.35 1.4 1.45 1.5 1.55 1.6
Nastri
PP

• Trasporta Uova
• Raccolta Uova
• Essiccazione Pollina

• Raccolta Pollina
4002 H
• Apertura a 360°
• Azione “SOFT”
• Materiale resistente e durevole
4006 H
• Apertura a 360°
• Azione “SUPERSOFT”

• Materiale resistente e durevole




4626

• Adatta per l’ingrasso dei tacchini
• Lettiere asciutte
• Abbeverata in simultanea di 2 e più animali



INFINITY

• Design dalle dimensioni ridotte





• Nessun pulcino nel piatto
• Semplice regolazione del livello di mangime
• Disponibile in versione da gabbia
4901 N
Regolatore di pressione con bypass

Corti Zootecnici Srl | Via Volta, 4 21020 Monvalle (VA) Italy| www.cortizootecnici.it | per
ARTICOLI
CORTI ZOOTECNICI
l’allevamento
ACCESSORI
World leader in incubators & complete hatchery solutions
















www.petersime.com
per tutti i tipi di uova. Specialisti in starne, fagiani e struzzi. Via Bancora e Rimoldi 3 – 22070 Guanzate (COMO) 39-031.352.91.22 – 031.352.91.29 - Fax: 39-031.352.95.91 E-mail: victoria@victoria-srl.com INCUBATORS SPECIALIST SINCE 1924 Incubatrici automatiche e digitali da 18 to 10.000 uova di capacità Via G.Galilei 3 – 22070 Guanzate (COMO) - Fax: +39-031.899.163 E-mail: fiem@fiem.it A.L.I. srl • via Salvador Allende, 75H 47043 Sant’Angelo di Gatteo (FC) Italia T: 0541 941673 • F: 0541 348781 • info@lohmann.it info@cobbvantress.com The Chicken Experts. Bábolna TETRA Kft. H-2943, Bábolna, Radnóti M. u. 16. tel.: +36 95 345 008 info @ babolnatetra.com www.babolnatetra.com AFFID A BILITÀ COMPE T ENZA T R ADIZIONE RIC E RCA QUALI TÀ aviagen.com ROSS 308 DELIVERS Ross Zootecnica Magazine Market Guide Ad - ENGLISH.indd2/10/201 1:34 PM aviagen.com Rowan Range Zootecnica Magazine Market Guide Ad Italian - ENGLISH.indd 1 6/5/19 11:05 AM Riproduttori
Incubatoi
Incubatrici
Riproduttori e
www.agritech.it – e-mail: commerce@agritech.it
Leader in pig & poultry equipment



THE MOST INNOVATIVE RANGE FOR POULTRY FEEDING


Via Roma 29, 24030 Medolago (BG) Italy - Phone +39 035 901240 Fax +39 035 902757 info@azainternational.it www.azainternational.it
Attrezzature
BELTS AND ROPES FOR AVICULTURAL US E
Manure removal belts an d Manure belt with holes for drying system s
Via Garibaldi, 54 – 26040 Scandolara Ravara (CR) Italy
Tel. (+39) 0375/95135 • Fax. (+39) 0375/95169 info@barbieri-belts.com • www.barbieri-belts.com
CARFED INTERNATIONAL LTD

Sede: Piazza Oberdan, 3, 20129 Milano
Magazzino: Via Basilicata, 10, 20098 San Giuliano Milanese
Tel.: +39 02 9881140 - Fax: +39 02 98280274
Email: carfed@carfed.it - Web: www.carfed.it
Sede UK: Ground Floor, One George Yard, Londra EC3V 9DF, Regno unito
Тel.: + 44. 20. 7660.0987- Email: carfed@carfed.co.uk
CODAF Poultry Equipment Manufacturers
Via Cavour, 74/76 • 25010 Isorella (Brescia), ITALY
Tel. +39 030 9958156 • Fax: +39 030 9952810 info@codaf.net • www.codaf.net
Corti Zootecnici Srl | Via Volta 4, Monvalle (VA) - Italy
Tel. +39 0332 799985 | info@cortizootecnici.com | www.cortizootecnici.it
www.bigdutchman.it
P OU LT RY E QU IP MEN T
The No. 1
TURNKEY PROJECTS
POULTRY INTEGRATED PROJECTS


POULTRY EQUIPMENT FOR BROILERS AND LAYERS AVIARY SYSTEMS
Officine Facco & C. S.p.A. Via Venezia, 30 - Marsango (PD) Italy
Tel. +39 049 9698111 - Fax +39 049 9630605 | www.facco.net - facco@facco.net
spazio55x45-facco.indd 2 03/10/14 15:06
impianti chiavi in mano
Sede Operativa: Via dell’Industria 9 46043 Castiglione delle Stiviere (MN)
Tel: +39 0376 636215 – Fax: +39 0376 1379121
Partner commerciale di: Viale dell’industria, 55 - 37042 Caldiero (VR)
Tel.: 045982022 - www.cizo.it - info@cizo.it

Attrezzature
GmbH & Co. KG
Dassendaler Weg 13 • D-47665 Sonsbeck (Germany)
T: +49 (0) 2838 912-0 • F: +49 (0) 2838 2791 info@specht-tenelsen.de • www.specht-tenelsen.de
VALLI spa • via Cimatti, 2 • 47010 Galeata (FC)
T: +39 0543 975 311 • F: +39 0543 981 400



E: info@valli-italy.com • I: www.valli-italy.com

Housing equipment for breeders, layers and broilers.





Giacomo Pallavicini Area Sales Manager South Europe giacomo.pallavicini@vencomaticgroup.com +39 3478626334
www.vencomaticgroup.com


ZOOTECNICA.IT
Sistemi di abbeveraggio per pulcini, polli da carne, galline ovaiole, pollastre, riproduttori, tacchini, conigli e suini Conveyor per la centralizzazione della raccolta delle uova

Sistemi di raffrescamento a nebbia e a pannello
LUBING via Marco Polo, (Z.I.) Campodarsego, Padova Italy tel. + fax + info@lubing.it www.lubingsystem.com
SISTEM SRL Italia lubingsystem.com
 PRODUZIONI CHIAVI IN MANO ATTREZZATURA AVI CUNICOLA
PRODUZIONI CHIAVI IN MANO ATTREZZATURA AVI CUNICOLA
MODULA
Tramoggetta specifica per tacchini
ROBUSTA E FACILE DA GESTIRE
Leader in pig & poultry equipment




8 ~ 10 marzo
VIV ASIA
Utilizzabile dal primo giorno fino ai tacchini maschi pesanti e nervosi.
International trade show from feed to food for Asia
IMPACT Exhibition Center
Bangkok, Tailandia
Montaggio e smontaggio dell’anello antispreco rapido, sicuro e senza l’utilizzo di attrezzi o viti.
Per informazioni:
VNU Exhibitions Europe
Tel.: +31 (0) 30 295 2700
Tappo del fondo facile da smontare per un lavaggio comodo e totale di tutte le parti della tramoggetta.
South East Asia
VNU Exhibitions Asia Pacific Co., Ltd.
NESSUN PULCINO NEL PIATTO
88 The PARQ, 4th Fl., West Wing Ratchadaphisek Rd., Khlong Toei,
American Poultry Connects

Minneapolis, Minnesota, Stati Uniti
Per informazioni:
Informazioni generali:
MONTAGGIO VELOCE E SICURO
P.O.Box 8800
FACILE PULIZIA
3503 RV Utrecht, Paesi Bassi
Tel.:
Email:
Web:
Abu Dhabi National Exhibitions Company (ADNEC)
Khaleej Al Arabi Street
P.O. Box 5546
3 ~ 5 maggio
Fieravicola
Centro Espositivo di Rimini
Rimini, Italia
Abu Dhabi, United Arab Emirates
Tel.:
Fax:
AGENDA 2023
AZA International s.r.l. Via Roma 29 24030 Medolago (BG) Italy Phone (+39) 035 - 901240 - E-mail: info@azainternational.it QUALITY MADE IN ITALY Visualizza tutte le informazioni su Modula www.azainternational.it
VOGLIO AZA!
GUIDA INTERNET
Agritech commerce@agritech.it
Albitalia infotecniche@albitalia.com
Albors info@albors.it
Ali Lohmann info@lohmann.it
Ascor italy_ascor@vetoquinol.com
Arion Fasoli info@arionfasoli.com
Aviagen info@aviagen.com
Aviagen Turkeys Ltd turkeysltd@aviagen.com
Aza International info@azainternational.it
Babolna TETRA info@babolnatetra.com
Barbieri Belts info@barbieri-belts.com
BD Agricoltura Italia S.r.l. italia@bigdutchman.com
Biochem ber tarelli@biochem.net
Biolab 2000 biolabvr@tiscalinet.it
Carfed International Ltd carfed@carfed.co.uk
Carfed International Ltd Italy carfed@carfed.it
Chick Farm Europe info@chickeurope.com
Cizo info@cizo.it
Clerici Gino S.r.l. info@clerici.it
Cobb Europe info@cobb-europe.com
Codaf info@codaf.net
Corti Zootecnici S.r.l. info@cortizootecnici.com
DSM Nutritional Products info@dsm.com
Elanco italia_elanco@elanco.com
EuroTier eurotier@dlg.org
Evonik luca.iacoianni@evonik.com
Facco Poultry Equipment facco@facco.net
FIEM fiem@fiem.it
FierAgricola Verona fieragricola@veronafiere.it
FierAvicola info@fieravicola.com
Gasolec sales@gasolec.com
GI-OVO B.V. sales@gi-ovo.com
Giordano Poultry Plast info@poultryplast.com
Hendrix Genetics info@hendrix-genetics.com
Hubbard contact.emea@hubbardbreeders.com
Hy-Line International info@hyline.com
Impex Barneveld BV info@impex.nl
Intracare info@intracareitaly.com
Jansen Poultry Equipment info@jpe.org
Lallemand animalitaly@lallemand.com
Lubing System info@lubing.it
Marel Poultry info.poultry@marel.com
Mbe Breeding Equipment info@mbefabriano
Meyn sales@meyn.com
MSD Animal Health S.r.l.
www.agritech.it
www.albitalia.com
www.albors.it
www.alilohmann.com
www.ascor.vetoquinol.it
www.arionfasoli.com
www.aviagen.com
www.aviagenturkeys.com
www.azainternational.it
www.babolnatetra.com
www.barbieribelts.com
www.bigdutchman.it
www.biochem.net
www.biolab2000.it
www.carfed.it
www.novogen-layers.com
www.cizo.it
www.clerici.it
www.cobb-vantress.com
www.codaf.net
www.cortizootecnici.it
www.dsm.com
www.elanco.com
www.eurotier.com
www.evonik.com
www.facco.net
www.fiem.it
www.fieragricola.it
www.fieravicola.com
www.gasolec.com
www.gi-ovo.com
www.poultryplast.com
www.hendrix-genetics.com
www.hubbardbreeders.com
www.hyline.com
www.impex.nl
www.intracare.nl
www.jpe.org
www.lallemandanimalnutrition.com
www.lubingsystem.com
www.marel.com/en/poultry
www.mbefabriano.it
www.meyn.com
www.msd-animal-health.it
MS Technologies info@mstegg.com w ww.mstegg.com
Newpharm info@newpharm.it
Officine Meccaniche Vettorello luciano@officinevettorello.it
Omaz S.r.l. omaz@omaz.com
Petersime N.V. info@petersime.com
Prinzen B.V. info@prinzen.com
Riva Selegg info@rivaselegg.com
Royal Pas Reform info@pasreform.com
Roxell info@roxell.com
Reventa info.reventa@munters.de
Sacco S.r.l. info@saccosystem.com
Schropper office@schropper.at
Ska ska@ska.it
Sime-Tek info@sime-tek.com
Space info@space.fr
www.newpharm.it
www.officinevettorello.com
www.omaz.com
www.petersime.com
www.prinzen.com
www.rivaselegg.com
www.pasreform.com
www.roxell.com
www.reventa.de
www.saccosystem.com
www.schropper.at
www.ska.it
www.sime-tek.com
www.space.fr
Specht Ten Elsen GmbH & Co. KG info@specht-tenelsen.de www.specht-tenelsen.de
Sperotto info@sperotto-spa.com www.sperotto-spa.com
Tezza tezza@tezza.it www.tezza.it
TPI-Polytechniek info@tpi-polytechniek.com www.tpi-polytechniek.com
Valli info@valli-italy.com www.valli-italy.com
Val-co intl.sales@val-co.com www.val-co.com
Ventilazione Industriale info@amboso.com www.ventilazioneindustriale.it
VDL Agrotech info@vdlagrotech.nl www.vdlagrotech.com
Vencomatic Group B.V. info@vencomaticgroup.com www.vencomaticgroup.com
Victoria victoria@victoria-srl.com www.incubatricivictoria.com
Direttore responsabile
Lucio Vernillo
Redazione
Daria Domenici (zootecnica@zootecnica.it)
Amministrazione
Marianna Caterino (amministrazione@zootecnica.it)
Ufficio
Zootecnica International
Vicolo Libri, 4
50063 Figline Incisa Valdarno (FI) Italia
Tel.: +39 055 2571891
Web: zootecnica.it
Registrazione
Registrazione Tribunale di Firenze n.3162 Spedizione in A.P. Art.2 comma 20/B legge 662/96 - Filiale di Firenze
ISSN 0392-0593
Abbonamento (1 anno / 11 numeri): Italia Euro 50
Abbonamento con Carta di credito o Paypal: zootecnica.it/abbonamenti
Abbonamento con bonifico bancario: Zootecnica International, Vicolo Libri, 4
50063 Figline Incisa Valdarno (FI) Italia; banca: UNICREDIT, BIC: UNICRITM1OU9 Iban: IT 81 H 02008 38083 000020067507
Art Direction e impaginazione
Laura Cardilicchia – elleciwebstudio.com
Copertina
© Denise Vernillo
Stampa
Nova Arti Grafiche, Firenze
Edizione italiana
Anno XXXIV • Maggio 2023
I posatoi Giordano Poultry Plast, realizzati in plastica di alta qualità, sono un prodotto di lunga durata, resistente alla corrosione e di facile pulizia. Tra i vantaggi dati dall'utilizzare dei posatoi così sicuri vi sono l'incremento della performance riproduttiva, la garanzia del benessere animale grazie alla larghezza delle griglie pensate appositamente per ridurre la rottura delle zampe e la possibilità per gli animali di dormire in un ambiente più salubre in quanto sollevati da terra.







www.poultryplast.com



Il cliente a cui teniamo di più
Per poter nutrire in modo sostenibile e responsabile i 9,7 miliardi di persone attese su questo pianeta nel 2050, il cambiamento deve avvenire adesso.
In DSM, la nostra passione e le nostre competenze si concentrano in 6 aree chiave per sostenere la filiera produttiva e affrontare le sfide del nostro pianeta:
• Migliorare le performance degli animali zootecnici durante tutto l’arco della loro vita
• Utilizzare le risorse naturali in modo efficiente

• Ridurre le emissioni degli allevamenti
• Contribuire a combattere la resistenza agli antibiotici
• Ridurre l’impatto sulle risorse marine
• Migliorare la qualità di carne, latte, pesce e uova, e ridurre gli scarti e gli sprechi alimentari
Crediamo fortemente in un sistema alimentare sostenibile e che il settore dell’allevamento possa trasformarsi dall’interno ed essere parte della soluzione. Vogliamo avere un ruolo chiave questa trasformazione e operare a livello di singola specie e nazione, assieme ai nostri partner, per fornire soluzioni tangibili e realizzabili e creare una vita più brillante per tutti.
Se non noi, chi? Se non ora, quando? NOI LO RENDIAMO POSSIBILE
Follow us on:
www.dsm.com/wemakeitpossible

S.P. Macelline1, P.V. Chrystal1, M. Toghyani1, S. Greenhalgh1, P.H. Selle1 e S.Y. Liu1
S.P. Macelline1, P.V. Chrystal1, M. Toghyani1, S. Greenhalgh1, P.H. Selle1 e S.Y. Liu1


























































 PRODUZIONI CHIAVI IN MANO ATTREZZATURA AVI CUNICOLA
PRODUZIONI CHIAVI IN MANO ATTREZZATURA AVI CUNICOLA












